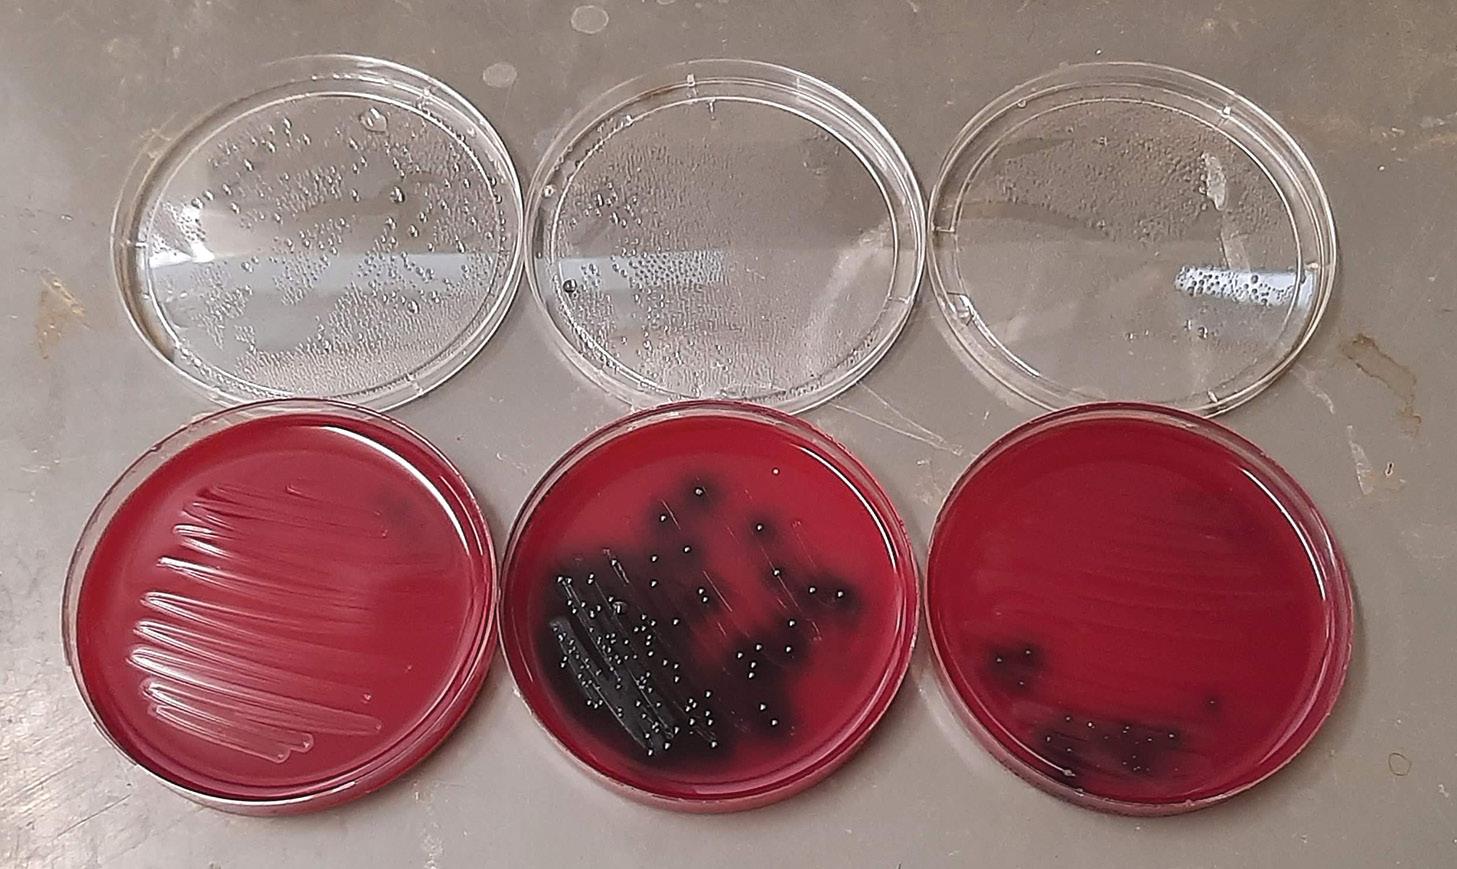

Our key reason for being in business is to help you grow. Both in respect to helping you improve the land you farm through technological and innovative techniques, also about helping you improve your bottom line and growing your business.
This is done by our people, without the experience, training and skill of our nationwide team we would be nothing. Our biggest investment in our organisation is in ensuring our people are operating at the best they can be.

Whether it is the specialists that back up our retail teams with technical product knowledge or our training for our service technicians, we believe our team makes us different from anyone else in the country. We pride ourselves on our service and we’re passionate about what we do. We have the benefit of local knowledge combined with a group knowledge that is second to none in New Zealand. We are a fully independent family owned group of companies with a three-generation 75-year history of serving the agricultural, construction, municipal and civil sector. Now with over 308 staff across 17 dealerships and
affiliated with another three independent dealers we’re proud to provide a full range of services for all your tractor, telehander, feed mixer, grass and cultivation machinery requirements.









We import the finest state of the art technology available in the world and back it through our dealership network. Our experienced national technical support team work alongside over 100 extensively trained technicians to ensure the diverse range of machinery used throughout New Zealand is consistently operating in optimum condition. With $20m worth of parts in stock, overnight



delivery available to most of New Zealand and nationwide integrated I.T. solutions, we make sure your gear continues to work as hard as you do. As a 100% kiwi owned and operated company we are committed to investing back into New Zealand throughout 2020 and into the future. Contact one of our dealerships near you to find out what it feels like to be part of the Power Farming team and enjoy the difference that we believe this will make to your business.





















Page 79
YOUNG COUNTRY
79 Farm workers: Filling the gap
WELLBEING
82 Grieving: Don’t forget about me…
RESEARCH WRAP
84 Nitrogen: Following the isotopes

DAIRY 101

86 Clover: Pasture’s nitrogen fixer
SOLUTIONS
88 Tech talk with cows
89 Beef farmer a winner
OUR STORY
90 50 years ago in the NZ Dairy Exporter
STOCK
74 Vet Voice: A lesson in stripping

76 Tackling lameness on Owl Farm

OUR COVER
Alan Gibson from Tauranga is the talented photographer who took the photos at Gavin Fisher’s organic dairy farm at Te Aroha.
Page 63
Hamilton will feature discussions about alternative ways of using Farmax to advance New Zealand farm systems. Well-known speakers and a scientist panel combine with Farmax workshops. To view the programme and to register go to www.conference2021. farmax.co.nz.
programme and to register, visit digitalag. events/digitalag-2022-programme-is-outregistrations-open. It will also be streamed online.
January 25-27 – New Zealand Dairy Event is held at Manfeild Agri-Centre, Feilding. It includes the annual sale on January 26 which will feature the pick of the herd from the famous Thurvalley Brown Swiss Stud where Tony Buehler and family offer the opportunity to pick your favourite cow, heifer or calf from the herd. Visit www.facebook. com/nzdairyevent.
February 9-11 – The 34th annual Farmed Landscapes Research Centre (FLRC) workshop at Massey University. More at www.massey.ac.nz/~flrc/workshops.html.
February 16-17 – National Freshwater Conference explores the Essential Freshwater Package, Resource Management and the Three Waters Reform. Find out more at www.brightstar.co.nz/events/nationalfreshwater-conference-0.
March 10 – Quorum Sense is running a bale grazing and regenerative agriculture field day near Wendonside in Southland. For details visit www.quorumsense.org.nz/ events.
March 17-19 – Central Districts Field Days in Feilding has been held for the past 28 years. To find out more visit www.cdfielddays.co.nz.
March 17 - Owl Farm plans a focus day on the Cambridge demonstration farm. To get more details about the farm and the latest farm data, visit www.owlfarm.nz.
March 30-31 – DigitalAg is the rebranded MobileTECH Ag and will take place in Rotorua for the 2022 event. It will showcase new agritech developments

March 31 – Entries close for the New Zealand Dairy Industry Awards including New Zealand Share Farmer of the Year, New Zealand Dairy Manager of the Year and New Zealand Trainee of the Year. Some changes have been made to the awards including an age range for trainees and no minimum time in New Zealand for the dairy manager category. The format for judging has also changed slightly. To find out more and to enter, visit www.dairyindustryawards.co.nz.

March 31 – Entries close for the Fonterra Responsible Dairying Award which recognises farmers who are demonstrating leadership in their approach to responsible dairying, have proven results and are respected by their farming peers and their community. For more about the award and to enter go to www.dairyindustryawards. co.nz/responsible-dairying-award.

Please check websites to see if events are going ahead at changing Covid Alert Levels.
Sprogramme run by Reporoa dairy farmer and cancer survivor Sarah Martelli, who helps other women find their balance and build strength and wellbeing to be the best they can be.
Strong Woman is an online community for women to work on their fitness with a workout to do at home, find quick and easy healthy recipes, goal planners and to connect with other women on the same journey.



Her philosophy is to help women create healthy, sustainable habits around moving and feeding their bodies and their families.
If women can prioritise their own health and fitness, they can inspire their partners, their children and their community around them, Sarah says (p82).
She is an inspirational woman creating a moment of lift for many women.
In this issue we take a look at the regenerative agri journey some NZ farmers are already on, and that the government has signalled they want others to join in on, in our Special Report.
(p42). We also cover the Heald family of (p52) who have transitioned to organics, philosophies and are enjoying the less intensive more resilient system they have moved to, improved profitability.





There is more research to be done in the system context, says MPI’s chief scientist figure out what will and won’t work, but farmers to engage and learn more, and to regenerative as a verb - saying all farmers be more regenerative, more resilient, lowering and building carbon storage.

So here we are at the start of another year…full of hope.
The regen debate has divided the farming community in a big way - many scientists are affronted that NZ would need regenerative methods from overseas countries with highly degraded soils - would that then infer that our conventional methods were degenerative?
Will it be another Covid-induced groundhog year? Or will this be the one where we actually come out of the other side of the pandemic and move into the new normal?
I can’t see us ever going back to the pre-pandemic days of jumping on planes and travelling the world without a mask or scanning device in sight, but it would be nice to at least carefully kick-start the tourism industry and have the odd overseas holiday.
equity growth of $97,000/year over the past three years - which they compute is equal to an annual salary of $245,000 in a town job.

If you are interested in getting into farm getting out but retaining an interest, read Moss’ innovative idea for a speed-dating potential partners (p11). We think it could
Not many couples in town jobs would have that level of combined income, nor would they be saving that much over and above their expenses, (pg 52) so we can confirm the dairy industry is still full of opportunities for growing great businesses.
They say the methods won't work, and that research has already shown that, and also our farmers are already following regenerative practices. Others say that the methods are not prescribed and each farmer can take out of it what they want. It has been called a social movement rather than a science and the claimed benefits of improved soil and stock health and building soil carbon through diverse species, use of biological fertilisers and laxer and less frequent grazing practices along with less nitrogen is something that resounds emotionally with many.
Top tips from five sharemilking couples drill down into their combined experience and wisdom which are mandatory reading for anyone embarking on the contract milking journey.
We have taken a snapshot of thinking by scientists in MPI and DairyNZ (p46) and portrayed what farmers using the practices are finding, including ongoing coverage of the comparative trial work by Align Group in Canterbury
This year 2022 will have some hard stuff for dairy farmers - the finalisation of He Waka Eke Noa or moving into the ETS will not be easy or palatable, but at least it is coming at a time when the payout for dairy solids could potentially be at an all-time high.
Because of the high payout and scarcity of good dairy workers, wages are likely to keep going up, which is a good thing for the workers, not so much for farm owners. Other costs are also under huge inflationary pressure and as always cost control and monitoring the budget are important.
In our special report on contract milking, it’s great to read about the fantastic growth in equity some contract milkers are achieving, with a mix of good production, controlling operating costs and running a successful contract milking business.
We profile a couple of very successful contract milkers and talk to DairyNZ experts. Their recent analysis of contract milkers’ financial records show the top 25% of contract milkers can save up to 30% of their income to grow their equity, with an average
As always, communication is highlighted as a very important skill - in each contract milkers’ new role of managing staff and also for managing the relationship between themselves and their farm owner. (Pg 57)
Owl Farm in the Waikato has managed to overcome their growing lameness problem, using data, systems and new processes and results are good for the cows and the bottom line (pg 76).
And a group of young people in South Waikato have banded together to form an innovative and very diversely experienced company providing relief and casual workers for the farming industry - resulting in wellpaid, interesting and satisfying roles for them. Sounds like a lot of fun. (pg79)






JULY 2021 ISSUE
• Farming/business investment – if you are starting out or bowing out.









•
•
• Sheep milking conference coverage
In the next issue:


February 2022
• Reboot your soil, reboot your life in Rerewhakaaitu
• Contract milking part 2
• What’s really happening in the United Kingdom dairy industry?

New Zealand Dairy Exporter’s online presence is an added dimension to your magazine. Through digital media, we share a selection of stories and photographs from the magazine. Here we share a selection of just some of what you can enjoy. Read more at www.nzfarmlife.co.nz
REGEN VS. CONVENTIONAL FERTILISER
We are tracking the comparative trials at Align Farms in Canterbury, this month taking a look at the fertiliser programmes. www.youtube.com/ watch?v=zoenATHDmyk
NZ Dairy Exporter is published by NZ Farm Life Media PO Box 218, Feilding 4740, Toll free 0800 224 782, www.nzfarmlife.co.nz
Editor Jackie Harrigan P: 06 280 3165, M: 027 359 7781 jackie.harrigan@nzfarmlife.co.nz
Deputy Editor Sheryl Haitana M: 021 239 1633 sheryl.haitana@nzfarmlife.co.nz

Sub-editor:
Andy Maciver, P: 06 280 3166 andy.maciver@nzfarmlife.co.nz
Reporters
Anne Hardie, P: 027 540 3635 verbatim@xtra.co.nz
Andrew Barlass and family are committed to ryegrass on their two Canterbury diary properties - he is trying out alternative forage mixes as well, but says that ryegass is the kingpin and the other species will be grazed in a way that is not at the expense of the ryegrass.
Take a look at our story: https://www.youtube.com/ watch?v=fLfhOACjd-U
Factum Agri is dedicated to New Zealand’s primary industry, working with the Rural Support Trust. Each week Angus Kebbell talks with farmers, industry professionals and policy makers to hear their stories and expert opinions on matters relevant to both our rural and urban communities.


Sinead Lehy
Interview with Sinead Lehy, principal agricultural science adviser at the New Zealand Agricultural Greenhouse Gas Research Centre.
Emma Taylor
Interview with Emma Taylor, general manager of Vineyard Plants in the Hawke’s Bay about viticulture. The company supplies vines, predominantly sauvignon blanc, to the New Zealand wine industry.
Fiona Bush
Interview with North Canterbury sheep and beef farmer, Fiona Bush. Fiona is giving her perspective on MPI’s Primary Industry Advisory Services available to the rural sector as well as the key issues farmers face today such as the environment and the rural/urban divide.
Find these episodes and more at: buzzsprout.com/956197
Maatua Hou. A bobby calf rearing venture with a twist - four young couples have set up an equity partnership, bought a 34ha block and created a venture where the farmers supplying the calves also pay. The farmers are guaranteed to get their money back when the calf is sold along with a share in any profit. Could this be a way to help reduce bobbies? Is there another way we could be rearing beef in this country?
Take a look at our story: ww.youtube.com/ watch?v=yLxdY5mkH8Y



MILK PAYOUT TRACKER:
2021/2022 Fonterra forecast price
Average $8.88/kg
CONNECT WITH US ONLINE:

www.nzfarmlife.co.nz
NZ Dairy Exporter @DairyExporterNZ
NZ Dairy Exporter @nzdairyexporter
Sign up to our weekly e-newsletter: www.nzfarmlife.co.nz

Anne Lee, P: 021 413 346 anne.lee@nzfarmlife.co.nz
Karen Trebilcock, P: 03 489 8083 ak.trebilcock@xtra.co.nz
Delwyn Dickey, P: 022 572 5270 delwyn.d@xtra.co.nz
Phil Edmonds phil.edmonds@gmail.com
Elaine Fisher, P: 021 061 0847 elainefisher@xtra.co.nz
Alex Lond lond.alexandra@gmail.com
Design and production:
Lead designer: Jo Hannam P: 06 280 3168 jo.hannam@nzfarmlife.co.nz
Emily Rees emily.rees@nzfarmlife.co.nz
Partnerships Managers: Janine Aish Auckland, Waikato, Bay of Plenty P: 027 890 0015 janine.aish@nzfarmlife.co.nz
Tony Leggett, International P: 027 474 6093 tony.leggett@nzfarmlife.co.nz
Angus Kebbell, South Island, Lower North Island, Livestock
P: 022 052 3268 angus.kebbell@nzfarmlife.co.nz
Subscriptions: www.nzfarmlife.co.nz subs@nzfarmlife.co.nz
P: 0800 2AG SUB (224 782)
Printing & Distribution:
Printers: Ovato New Zealand
Single issue purchases: www.nzfarmlife.co.nz/shop
ISSN 2230-2697 (Print)
ISSN 2230-3057 (Online)




You don’t know what you know.
You know you don’t know how to do something.
Consciously Competent
but still need to think.
How many of you became farmers because you wanted to be a people manager?” was one of the first questions asked at a workshop I recently attended. Out of the 20-something farmers in the room (all of whom are employing people), none could say that was the reason we became farmers.
The workshop was the first in the series of the ‘Primary Sector People and Team Leadership Programme’ and I would highly recommend the programme to any farmers who are managing or hoping to manage staff.

Funded by MPI and hosted by Great South, the programme designers recognise that progression in the farming industry often results in the need to employ and manage people, but farmers don’t usually get sent on ‘people management’ or ‘team leader’ courses the same way other industries do, and, as a result we miss out on the knowledge which makes the people management side of the job easier, legally compliant, and consequently more enjoyable (or at least less painful).

Realising an experienced person can forget to explain parts of a task – because it’s so second nature to them – and an inexperienced person doesn’t know what to ask about – because they don’t know what they don’t know – has got us rethinking our expectations.
I believe we got so much out of the course because both Duncan and I attended.
I am quite partial to a training course (particularly if it involves lunch and a free pen) but getting Duncan along to this kind of thing can be a challenge, and since it is Duncan who is working with people day in and day out, it would not have had the same impact if he hadn’t been there as well.
Our key takeaways were the different stages of learning, understanding personality differences, sharing farm goals,
and illustrating individual training and progress.
You know how to do something - it is common sense.
We learnt that few people are motivated by money or rewards, which seems hard to believe when an employee leaves for another farm offering more money. But it turns out understanding the big picture of what the business is trying to achieve, being given autonomy, and seeing their training record filling up is more likely to retain a team member than an overly large salary or gradefree bonus.
It’s no surprise that a team will be made up of different personalities, what is surprising is how little we have been taking that into account when running our farm.
An early exercise was for our farm team to complete the DOPE test (Dove, Owl, Peacock, Eagle) which identifies a person’s style and then explains the strengths, risks and how to get the best out of someone with that style. It has made us think about how to communicate, interpret, and motivate our team.
Understanding the stages of learning was a real eye opener for us. We can have someone who knows the job inside-out training someone who has never done it before. Realising an experienced person can forget to explain parts of a task –because it’s so second nature to them – and an inexperienced person doesn’t know what to ask about – because they don’t know what they don’t know – has got us rethinking our expectations.
We are far more enthusiastic about putting our learning into action on the drive home than the reality of being back on farm allows, but we are taking steps to get there. Training charts have gone up on the wall, the personality test has been added to the new starter pack, and we are working out how to best explain the big picture to our team. Interestingly, none of these initiatives cost a thing.
I’ll be the first one to say that I was a cynic as I watched alternative milking mammals rising to fame. More people than ever were milking goats and sheep, and now there are whispers of deer, and here’s me thinking what’s wrong with a cow? So, when some friends approached me about spending JulySeptember rearing lambs on a local sheep milking farm, I thought I’d better give it a go and see what all the fuss was about.
After years of rearing calves, I was optimistic about my capabilities with lambs, but I had no idea what a huge operation it would be, or indeed how much I would learn on the job! The main difference was that my main purpose, 12 hours a day, alongside a team of three other full-time lamb rearers, was to make sure every lamb remained well fed and healthy.
We fed up to 1600 lambs four times a day, first with ewes’ colostrum and then milk powder, and conducted regular health checks on every lamb to ensure no infections were getting picked up or passed on. I felt like I finally saw into the life of a full-time calf rearer, and it was a great feeling knowing that you were one of a small group of people who were producing the next generation for the farm.
A major difference to calves was that these lambs stayed on mum for three days before we took them into the rearing unit. They were also all born inside, and these two factors gave them the best chance to survive and adapt. It meant keeping a keen eye on both the ewes and the lambs once they were born, making sure that no lambs were left unmothered and that ewes weren’t contracting mastitis.
There was a meticulous process involving numerous chalk colours to ensure each lamb was aged correctly, and much like cows we regularly drafted out lambed ewes to give them access to more room and tucker with their new-born lambs.


On the third day, we would complete the ‘lift’, where we moved the lambs into the lamb rearing unit and the ewes into pens ready to be milked that afternoon. Like with calves, this was a pain-free process, with mums ready to move outside on to fresh tucker and lambs already thinking about their next feed.
While I already had a lot of respect for full-time calf rearers before this job (most of all for their unwavering patience, something which certainly does not come to me naturally) this has increased a thousandfold. Furthermore, while my
After years of rearing calves, I was optimistic about my capabilities with lambs, but I had no idea what a huge operation it would be, or indeed how much I would learn on the job!

knowledge on sheep milking has grown so has my ability to understand why people are looking at alternative methods to cows.
Sheep seem to adapt naturally to the milking process, they are just as easy to feed, and you are able to milk more in a smaller space of time. The bobby calf issue faced by a lot of farmers is not a problem here; we reared both the ewe and ram lambs and the farm used their own rams during mating, while lamb rearers off farm would take on any excess to be finished or used on lifestyle blocks.
Ultimately, however, what keeps me on the side of cows is that I can absolutely, definitely, without a doubt confirm that sheep smell worse…
Normally working with cows, Alex Lond got an opportunity to experience life in the burgeoning sheep milk industry rearing lambs.Milk feeder. Ewe and three lambs.
If you asked me 10 years ago what I intended to do in the future, not from a farming background, dairy farming would never have crossed my mind. Now here we are 50/50 sharemilking two neighbouring farms with kids in tow, planning to succeed in our chosen profession as well as making the most out of what our place in paradise has to offer.
It has been an incredibly interesting ride to get here, my husband Cam and I had settled down originally in Te Awamutu, Cam was agricultural contracting while I was working in retail. We started our family together and saved enough to buy our first home. We had our first daughter and not so long after our second was on the way. Cam had now been contracting for a few years and had progressed as far as he wanted to climb. With our growing family, the late nights and busy seasons had prompted him to reconsider our career path.
Cam had been raised as a farm kid and decided it was a good lifestyle to raise children. We applied for a handful of jobs and were fortunate to be selected by Andrew Clark, a farmer in my hometown of Opotiki. We sold up (unfortunately before the property boom) and moved home.

currently in the process of buying everyone out a year early. It’s been a massive learning curve, considering I had never milked a cow in my life, to be thrown into solo milkings in our 24-aside Herringbone dairy, raising calves and now three children in tow.
For a couple of years Cam worked for Andrew and Kelly, his partner, with a goal of eventually sharemilking in mind. Conversations with Andrew progressed into a shareholder partnership along with a group of farmers from our discussion group, one being our neighbour Colin.
When the right job happened to come along, I never would have imagined it would be the quaint 300 Jersey cow farm I could see from my grandmother’s house. Everyone put in a share with us being the majority shareholders and the aim was to buy everyone out within five years. We are

We bought the owner’s cows and have kept the herd predominantly Jersey. The first season was a big adjustment especially with having each other to work with. We’ve been fortunate to have a good team of people around us for advice and now we feel like we know our farm and our cows well. We know when the farm grows grass and that in summer all we have to count on is kikuyu, as the ryegrass disappears.
After four seasons here our neighbour Colin sustained an injury requiring surgery and deeming him unfit to run his farm. With six weeks before the new season we accepted the job of 50/50 sharemilking his 250 cows and promptly found someone to help us run the daily tasks.
It’s been a mammoth task and we’ve had to prioritise running the farms above having our own time out. With a foreseeable favourable payout we are hoping to be a few steps closer to our dream of farm ownership.

We applied for a handful of jobs and were fortunate to be selected by Andrew Clark, a farmer in my hometown of Opotiki.


Peter Arthur offers advice on selection, costs and care.
If you are planning to plant trees next autumn or winter, now is the time to decide what species you want, and where you are going to plant them. Then put your order in.
I get mine from Appletons Nursery, near Nelson who supply plants bare-rooted from June till August but many lines are quickly sold out so it pays to order early.
You have to order a minimum of 10 for any given tree but the price per tree is very cheap. For example, Scarlet oaks (Quercus coccinea) 1.2-1.5 metres high are $13.40 each. If you buy 50 the price is $7.90 plus gst and freight. If you get a thousand, the price is still cheaper. The same tree, a bit bigger (1.6m) and in a pot will cost about $60 at a garden centre.
Appletons grow a huge range of trees, both natives and exotics, and sell many as growing-on lines, small plants from 15-25cm high, and upwards at even cheaper prices - the Scarlet oak being $2 each.
These small plants need growing-on in a nursery bed for a year or more before planting out.
In the autumn Appletons spend several weeks roaming New Zealand to collect seed from particular trees and in some years there is a good amount of seed, in others none at all for certain species.
This means some years they will have a certain species for sale, other years they won’t. This mostly applies to the more uncommon trees like Davidia involucrata (the Handkerchief tree) and Sequoiadendron giganteum (the giant redwood or Wellingtonia).
As well as trees they supply smaller-growing native plants for riparian planting, plus of course all the major forestry species.
Prior to planting, spray the spots with Roundup and you can add Terbuthylazine for longer-term weed control. It’s best to do this at least six weeks prior to planting.
If the area is already fenced off and there is lots of really long grass I take old salt lick containers and the like and pre-dig the holes, putting the soil into the containers. This way it doesn’t get lost in the long grass, and in the recent dry years we have been having in Hawke’s Bay any rain we do get is not only going into the hole, but also into the soil in the container, a double dose of moisture. If the ground is
really dry I add about 20 litres of water when I plant. Once the tree is planted it will need to be kept weeded for the first few years. I have tried all sorts of plastic weed matting and old carpet but this year have used dag wool which is easy to apply and which to my surprise, doesn’t blow away in the wind. It is also meant to act as a bit of a hare and rabbit deterrent, but I can’t vouch for this.
Newly planted trees in very short grass seem to attract hares and rabbits. Long grass seems to deter them so long as you take long strides and try to avoid flattening it so you haven’t made a convenient track from tree to tree.
Over the past 50 years I have used all sorts of tree barricades, starting off with 44 gallon drums. Of course I couldn’t run cattle around those trees for a year or two.
I then used taller weldmesh type netting but am now on to X fence security netting 1.8m high which I cut into about 2m long lengths. This, anchored with two waratah standards, costs about $100 a tree.
Newly planted trees in very short grass seem to attract hares and rabbits. Long grass seems to deter them so long as you take long strides and try to avoid flattening it so you haven’t made a convenient track from tree to tree.
It has worked well provided there is something else in the paddock for cattle to rub on. Cattle will use the barricade as a back scratcher with unfortunate results.
I am now trying, for the first time, Cactus barricades imported from Spain by Tree Guards NZ. These come in packs of 10 and measure 1.7m high by 1m long and cost $49 plus gst per barricade. Every second horizontal wire has been cut and sticks out like a very sharp barb. It makes for a narrower barricade than I would like but I am using them to replace X fence barricades on which the cattle have been rubbing.
• First published in Country-Wide, October 2021
Towards the end of 2021 fears of a global food crisis started to ring out as fertiliser production slowed in Europe and key exporting nations turned their supplies inward to ease the risk of their own food insecurity.
New Zealand farmers may have shown little immediate concern for Europe’s problems, but they have quickly been part of the collateral damage as fertiliser prices have reached recent record highs. At the beginning of December urea was priced at about $1200/tonne. A year earlier it was under $350 and as recently as September 2021 was $590/t.
Believe it or not, NZ farmers are by no means the worst affected from what has unfolded, and despite perhaps feeling they’re being held to ransom, there are still some things farmers can do to limit the cost pressure.
The fertiliser price spike can’t simply be attributed to Covid-19 like many other inflationary cost increases. Instead, the last 12 months has seen a series of influential events that have collided at exactly the wrong time.


First, at a global level, food commodity prices started rising, prompted to some extent by displacement of labour at key seasonal timings – which was a Covid-19 derived factor. Global wheat, soy and corn prices increased to levels not seen since 2014 while meat, dairy, rice and edible oils have all followed the move.
As a direct result of this, demand quickly started rising for fertiliser to replenish soil nutrients that had been allowed to run down when commodity prices were not at levels that encouraged maximum production. This kicked in early this year, ahead of the northern hemisphere spring at exactly the same time that supply constraints started to emerge.
In the United States, several weather events stifled fertiliser production including a significant seasonal ‘freeze’ which impacted the manufacturing of nitrogen, and later there was some disruption to phosphate production due to Hurricane Ida. But the biggest handbrake was rising gas prices in Europe. The price lifted quickly to a point where producers of nitrogen simply stopped working because
Disruptions in gas supply and export bans by China have hit international fertiliser supplies. Phil Edmonds reports on thae effects on New Zealand agriculture.
they could no longer make money. Rabobank senior agricultural analyst Wes Lefroy says soaring gas prices effectively shut down 12% of Europe’s nitrogen production.
If this wasn’t enough to fuzz the market, China simultaneously slapped export restrictions on its fertiliser exports with domestic fears over food security. China itself had experienced some electricity shortages and its supply has been compromised by the introduction of environmental measures which has impacted the phosphate market.
Ballance Agri-Nutrients sales general manager Jason Minkhorst says this move can’t be underestimated in pushing up prices.

“China had previously exported 35% of the world’s DAP and this year it will be 20%, with the export ban expected to stay in place until mid-2022.”
So, what does the northern hemisphere’s woes have to do with NZ, and why are China’s actions a big deal when NZ is not particularly reliant on its fertiliser exports?
Wes Lefroy says that even though NZ imports of fertiliser may not come directly from China,
it is now facing competition in other markets from countries caught out by China’s blockade. The Middle East (particularly Morocco and Saudi Arabia) has seen demand for its nitrogen rise, and with it prices.
Finally, a further disruptor that is felt more in NZ than many others is the rise in Covid-19related transport costs. Lefroy says shipping is still congested.
“Eighteen months ago, it took between six weeks and two months to get a laden ship berthed in your own port. Now it is taking
between three and five months between procuring and landing.” Inevitably this means extra cost tied up in delays.

LactisolTM Nucleus Z1 is armed with zinc oxide, vital in the battle to prevent facial eczema. However, only Lactisol Nucleus Z contains Hy-D®, to improve calcium adsorption, blocked as a side effect of high levels of zinc. And of course, Lactisol Z contains the full SollusTM range of vitamins, trace minerals and antioxidants needed to make your herd healthy and robust. Ask your feed supplier for the newest hero and give yourself a fighting chance.
registered
When facial eczema threatens, you turn to a hero that has a few tricks up its sleeve.
‘China had previously exported 35% of the world’s DAP and this year it will be 20%, with the export ban expected to stay in place until mid-2022.’Rabobank senior agricultural analyst Wes Lefroy.
Ravensdown general manager Mike Manning says “If we’re picking up from an international port that’s been affected by a Covid outbreak, we can’t load when booked. Similarly, if large manufacturing plants have to temporarily shut for the same reason, product may not reach ports when anticipated.”
There’s no getting away from the fact NZ is heavily exposed to global fertiliser prices. But we are not necessarily as badly off as some others – which may be worth keeping in mind, even if it’s cold comfort to farmers seeing their core costs of production escalate.
In Australia for example, there has been a heightened sense of anguish over the past few months, to the extent that predictions were being made of fertiliser rationing and lower yields as a result. Both short, and long-term solutions to this have been discussed in Australia including changing crop rotations to favour crops that produce nitrogen including pulses and investigating the potential for domestic manufacturing of cheaper and greener fertiliser.
Nothing of this drastic nature has been mooted in NZ, however.
Mike Manning says Australia has a more limited window to apply fertiliser with its primary focus on arable crops. By contrast, NZ’s pasture system allows more flexibility and time to adjust to prices. For example, many farmers might plan to put fertiliser on in November, but it is not the end of the world if it is delayed a month. Rabobank’s Wes Lefroy notes that Australia typically imports 65% of its urea between April and July. In NZ it is spread throughout the year, albeit with a peak in the final third of the year.
A possibly more significant factor is that the majority of fertiliser in NZ is sourced
from the two leading co-ops, which being farmer-owned and effectively mandated to ensure supply is available when needed, means they are likely to hold more product in storage, and less likely to run out. In contrast the Australian industry is dominated by corporates, who by their nature are more likely to try and trade with less stock.
Add to that, NZ has the benefit of local production. Lefroy notes the Taranaki urea production plant certainly takes the pressure off the reliance on imported nitrogen in the North Island. It can enable imports to be more directed to the South Island, which gives another blanket of supply security.
While NZ farmers may have more confidence than their counterparts in other countries that the fertiliser cupboard won’t be bare when they need it, they are nonetheless faced with elevated prices, potentially for longer. Lefroy says if the


global price dropped
50% tomorrow, it would still take a good few months to flow through given the shipping delays spoken of above. So, what can farmers do to ease the cost pain?
Understanding potential margins and considering your appetite for risk are good starting points, suggests Lefroy.
If, for example, farmers have confidence the forecast high milk price will be realised, it probably makes sense to maintain higher soil nutrient levels albeit within regulations. But if margins were to tighten farmers could instead look to utilise the nutrients they have built up in the soil.
If farmers are more inclined to stick with
planned fertiliser applications, they should be considering at what stage to make purchases. This involves weighing up the risk of missing out on a fall in prices in the autumn or the following spring versus locking in supply albeit at higher prices.
As far as the co-ops are concerned, providing advice on precision agriculture remains a key focus.
Mike Manning says just as Ravensdown can’t do much about international fertiliser prices, nor can farmers. However, farmers can look at being more diligent and a bit more prudent about how they use it.
“One of the ways to use nitrogen more efficiently is to be really clinical about feed supply and demand, considering where the gaps are. This can involve soil testing every paddock which gives farmers the ability to be more precise about soil deficiencies.”
Manning says Ravensdown are being asked for advice more than in the past, and this reflects a desire to be more efficient.
Ballance’ Jason Minkhorst says providing expert knowledge is the co-op’s business. He says there’s no sense farmers are deliberately wasteful, and indeed they can’t afford to be with the introduction of nitrogen limits. But there is clearly a renewed focus on efficient nutrient use.
One option to reduce exposure to high prices is for farmers to decouple their use of nitrogen and phosphate by shifting away from imported DAP toward locally manufactured phosphate. This allows farmers to more precisely dial up or down their use of nitrogen as necessary.
Minkhorst suggests the price hikes present farmers with an opportunity to reassess long-term fertility plans. This is something farmers make decisions on every year – understanding how they might treat areas with naturally high levels of phosphate differently to areas they have invested in to improve the fertility, and how they might use that fertility in a year where the payout may not be as supportive.
As to fears of global food shortages with the price of, and access to fertiliser becoming prohibitive, there’s no sense that it will slow NZ’s food production, particularly as we continue to see high farmgate prices for that production.

In terms of other markets, Lefroy says there is some reason to be concerned, but at the moment Rabobank is not expecting any decreases or shortages in food.

“India, which is doing a lot of buying at the moment, recently put out a tender for 1.6m tonnes of fertiliser and were offered 2.6m t. This shows there is still supply in the market.”
As to the coming 12 months, Lefroy says we may see the price of nitrogen come off between 10 and 20% if gas prices ease. But as commodity prices remain high then fertiliser prices will likely remain elevated. The second half of next year could start to see things ease, if China comes back to the global market in June. That’s still quite a long way away.
The key message then for farmers from both a financial and productive perspective is don’t expect a material fall in price anytime soon, and given that, precision is the best form of mitigation.
In demand: Dutch dairy cows.
In the past year, various milk processors in the Netherlands have started looking for more milk. What is going on? Demand for dairy is good, stocks are low and milk supply has fallen by 4% in recent months compared to last year. Added to this is the political uncertainty about what will happen to the numbers of livestock kept. Shrinkage is very likely.
For a milk processor, there are then two options: Closing factories and disposing of the less profitable contracts is the first. This strategy is particularly obvious at FrieslandCampina, where a total of 272 million kilograms of milk will disappear next year.
Since the abolition of the milk quota, the Dutch market leader has already closed 13 factories and with the departure of the 239 farmers this year, capacity adjustment is again necessary.
The second strategy dairy processors can follow is to bring in extra milk. And that is now happening a lot. How remarkable is that and why is Dutch milk so popular? Isn’t the dairy market preeminently a market with an international playing field?
Analysts say: “The Dutch label has a
positive perception in the market that is strongly embedded. In the first place thanks to the consistent quality of Dutch milk, but also because of the positioning with grazing, clogs and windmills. That is not just marketing, it is based on 50-60 years of consistent quality and security of supply.”


There is another reason. Customers ask for ‘KKMcertified’ milk. This is milk guaranteed produced in the Netherlands under Dutch quality standards with a low environmental impact. Moreover, transporting milk is expensive, especially today. Milk is 87% water, processors cannot drive far with it. All in all, the dairy market is apparently a lot less international than
Another development is that of ‘sustainable milk projects’. Never before have they been so diverse and numerous as at present. Ten years ago there was conventional and organic milk, now there are all kinds of concepts: meadow milk, GMO-free, Planet Proof, specific supermarket-concepts, Caring Dairy and the ‘Better life quality mark’ of the Animal protection organisation. These milks are less suitable for trade between factories, which is why factories would like milk from their own dairy farmers. The question is how the battle for milk will ultimately turn out and how long it will last. In theory, if factories closed, an equilibrium would be restored, provided they were not taken over by other processors. Analysts predict the action in the milk market will continue for a while.
previously thought or imagined.
Trading via the day-to-day market also offers no solace. With continued good demand and supply drying up, this is a small market. With additional processing capacity in the Netherlands, the amount of milk from the day-to-day market will no longer increase quickly.
‘The dairy market was boring for a long time, but now there is good money to be made again, also with commodities. Apparently companies need a trigger to take action.’
‘That is not just marketing, it is based on 50-60 years of consistent quality and security of supply.’• Sjoerd Hofstee is a dairy journalist at Persbureau Langs de melkweg, Netherlands.
MAXSYN
Diploid perennial ryegrass
Setting the pace for next gen pasture

Tetraploid perennial ryegrass
Extra palatabilty and environmental benefits
@BarenbrugNZ facebook.com/BarenbrugNZ
barenbrug.co.nz

What an interesting year 2021 has been for dairy commodity prices, however, we’re at a point where lofty prices start to spook people. Some people are starting to compare this season to the last time dairy commodity prices saw these heights; the 2013-14 season.
At that time, the market was very different, and that season’s high farmgate milk price was followed by a crash in the price the following season. So, let’s look back at 2021’s dairy commodity price movements, and then discuss why it is unlikely that we will see the same boom and bust of the 2013-14 season.
At the start of 2021 dairy commodity prices hit dizzying heights, in March whole milk powder hit a magical US$4364/ tonne at the March 16 Global Dairy Trade (GDT) event. Butter was the only other key commodity offered on the GDT platform that was able to achieve a similar gain at the same auction, while the other key reference products did not manage such a dazzling price gain.

At that time, Asian buyers were keen to secure much-needed WMP and butter supplies on the way into the winter lull of production. Then, as with now, shipping disruptions were a major issue on the top of mind of all buyers, making New Zealand’s ability to get product to market very attractive.
This was the first high point of 2021, but it didn’t take long for both WMP and butter prices to settle down to land in a new price range as NZ was heading into winter, and peak milk was flowing in the Northern Hemisphere.
Over the second half of 2021, the market changed tack remarkably, with a significant shift towards protein, with less concern for WMP. As the perfect example, the NZX casein price has increased 50% from the start of 2021, currently sitting at US$12,900/t. This casein price is an
amalgamation of all casein and caseinate prices, so it is best to take with a grain of salt, but the premise remains, the market is chasing these protein products, with buyers willing to push prices ever higher to secure supply. These buyers are also not from our regular markets, with the majority of these products heading to the United States.
Cheese prices have followed similar trends to casein, but more impressively, exploding over the last two months. Cheese prices at the end of 2021 are 29% higher than where they started the year. And, in an almost unheard of trend in the world of commodity trading, the complementary product of cheese production is also in hot demand, whey. Whey prices are being pushed to levels that have some in the industry in disbelief. With two of the world’s biggest cheese producers, the US and the European Union, struggling to grow their milk production, in year-on-year terms, there seems little doubt that cheese, and therefore whey, will be in tight supply going forward. NZ cheese prices are the most expensive globally, but buyers, such as Japan, are still willing to pay these high prices to secure their much-needed supply of NZ cheese. China’s demand for whey is unlikely to diminish in the short term.
Like the proteins, the evertasty part of the dairy industry, the cream group, has been on a steady climb higher through 2021. As mentioned earlier, butter prices exploded higher in March, but trended lower through winter, before shifting steadily higher.
Anhydrous milk fat (AMF) prices didn’t peak in March quite like butter prices, but did trend slightly lower in winter, before marching ever higher over the second half of 2021. Together, butter and AMF prices are now at seven-year highs. Demand for both products is very steady and is being helped by the real lack of exports coming out of the EU and US. During the 2013-14 season, the cream group didn’t see any real value gains, compared to the
boom WMP and SMP prices managed. So, how is this different to the 2013-14 season? Well, in 2013-14 there was a major shortage of WMP in China, so the Chinese government encouraged importers to reinstate their inventories, and thus the rush of demand for WMP… This time around, as mentioned above, the dynamics are very different.
Proteins are in the driving seat, with strong global demand for an array of milk protein products. The cream group has formed a solid price base, due to demand for protein products. Processing of these products moves milk away from production of cream derived products; tightening milkfat supply globally. Adding to these factors, the outlook for WMP looks very solid, with stream return calculations also likely seeing excess milk flowing away from WMP driers, into other processes, further tightening the global supply of milk for WMP.
Looking forward, we’re seeing a global market that is unlikely to fulfill its requirements in the short term, as milk production remains tight, and is likely to get tighter over the short term.
Shipping remains another key issue buyers are willing to pay a premium for, as global shipping remains very disrupted. Only when these two market factors return to balance, will it be likely to see downward pressures return for the NZ farmgate milk price. However, from what we’ve seen over the last year, it’s not going to be a fast turnaround.

“Changing ballcock arms was a daily routine job for me during the summer months, taking up time and causing stress and frustrations when water was scarce. Since inventing the Springarm and using them on our farm, over the past 18 months, we have not had a single broken ballcock arm.”

 Ric
Ric
Awburn,

 Dairy Farmer, Waikato, Inventor of Springarm
Dairy Farmer, Waikato, Inventor of Springarm




Cheesemaking at Fonterra’s Edendale site in Southland celebrates 150 years this month.
After celebrating 150 years of New Zealand’s first dairy cooperative in spring last year, Fonterra has another milestone this month.
On January 18, 1882, 140 years ago, the first batch of cheese was produced and placed on the press at 3pm at the Edendale dairy factory.
The milk for the cheese came from the factory’s own herd of 300 cows.
Sheep had proved unprofitable on the new pastures at Edendale owned by the New Zealand and Australian Land Company so in 1881, the company’s superintendent, Thomas Brydone from Scotland, thought dairying would be better.
Brydone made sure lime and fertiliser was added to the young grasses and they soon flourished. The Edendale Dairy Factory Company Ltd was born.

The same year, 1882, the SS Dunedin began sailing to England loaded with refrigerated mutton and lamb. Brydone made sure Edendale butter and cheese was onboard too.
By the early 1900s, Edendale was processing 3000 litres of milk and, in 1920, milk pasteurisation was added, a first for the country.

Its cheese was sold under the Pioneer label.
In 1914 all the whey from Edendale was processed into lactose milk sugar (1387 lbs), a first for the Southern Hemisphere, and sold under the brand name Wyndale.

Lactose is still produced under the Wyndale brand at Fonterra Kapuni in Taranaki.

A contractor’s tip truck was fitted with a removable 7000 litre tank in 1958 and
By Karen Trebilcock.became Edendale’s first milk collection tanker for farm pickups. Before this, farmers delivered their own milk to the plant.
In 1987, the first of what are now three Anhydrous Milk Fat (AMF) plants was commissioned (0.5 t/hr) to process whey cream and the first night collection of milk started.

In 1994, Drier 1 commenced production, processing 900 cubic metres/day of Whole Milk Powder (WMP) and Skim Milk Powder (SMP).
Drier 2 powder plant was commissioned
Still proud of its history.
in 2002 (2500 cu m/day WMP and SMP), Drier 3 the following year (2500 cu m/day, WMP and SMP, 11 M litre site capacity) and in 2009 Drier 4 (4000 cu m/day WMP 15 M litre site capacity) making Edendale the largest raw milk processing site in the world at the time.
Edendale’s 2015 expansion project involved building four new plants on site –a milk protein concentrate plant, a reverse osmosis plant, a milk treatment plant, and an anhydrous milk fat plant. It now has 13 plants making it one of Fonterra’s largest processing sites.
Cheese Plant manager, good things do take time just like in the TV ad. But it’s not the cheese he’s talking about, because at Edendale they can turn liquid milk into a 20kg block of cheddar in about five and a half hours. Instead, he’s talking about his career.
He started at the Edendale factory from his family’s Southland sheep and beef farm at 18, in September 1975, as a cheese hand and is now the plant’s longest serving employee.

Of the 140 years of history of the plant, he’s been there for a third of them.
“I was due to finish up school and I didn’t know what I wanted to do next. I got offered the job at Edendale, my dad knew the plant manager, and I started the very next day.
• Collects milk from more than 800 southern farmers with a fleet of 65 tankers
• Processes up to 15 million litres of milk per day at peak
• Exports products to more than 70 markets throughout the world
• Employs more than 670 people
• Produces 14 million bags of milk powder annually which if laid end-to-end would reach from Invercargill to Dubai
• Milk powders include whole, skim, butter, fat filled and milk protein concentrate, each specialised for customer needs
“It was daunting at first, with all of the white lab coats, boots and hats and you had to be fit with all of the manual handling.
“Some people didn’t last their first day. We worked seven days on and one day off and our wages were split between us so when we were short staffed we made a lot of money. One year I worked three months without a day off.
“In those days you worked hard and then you played hard. There were plenty of events – we were one big family and you just enjoyed each other’s company.
“It was a lot of fun, making cheese, there was also a cheese bar on site, so you got to see locals loving the product as well.”
When he started, the changeover was happening from farmers bringing their own milk to the factory to milk tankers only. From a cheese hand, he worked at CIP (clean in place), then as a pasteuriser,
Edendale Cheese Plant manager David Thwaites.
a starter, a salter operator, supervisor and finally, for the past 25 years in management. Although Pioneer branded cheese from Edendale could be bought in New Zealand until about 15 years ago, now all of the cheese produced at the site is sold on the Global Dairy Auction.

“We’re a peak milk plant so we run from September until the start of December each year and all of the product is exported. It can go anywhere in the world.”
A 12-hour shift produces 47,000kg of cheese.
“It hasn’t really changed since 1882. It’s still the same cheese, made the same way. It’s just more automated now and we make a more consistent product.
“The cheddar is made using microbial rennet starter cultures which comes from Fonterra Palmerston North, and then it’s pH controlled through the process and salt is added.”
Mild cheddar is about two months old, tasty is six to nine months and veteran is nine months to a year and a half.

“It’s all about the temperature as well. We keep our cheese at 4C but if it’s at say 10C it ages a lot faster.”
David says the great taste of Edendale cheese comes from Southland’s cows and the grass they eat and he’s a fan of veteran cheddar – “something with a bit of bite”.
“The milk from our cows down here brings out the best flavour. It’s a very exportable cheese. We have a wall of awards from New Zealand and Australia, and from all over the world including Europe.
“It’s something we’re very proud of.”
Grazing principles include vertical grazing on Gavin Fisher’s organic dairy farm at Te Aroha. Gavin is farmer ambassador for the Organic Dairy Hub Coop NZ Ltd. He talked to Sheryl Haitana about how he’s creating a future-proof farming business.
Any tree planted on Gavin Fisher’s farm during the past 41 years has had to tick as many boxes as possible: shade, shelter, habitat, nutrient cycling, produce, dietary and health benefits for the cows to name just a few.
Gavin associates all the trees, shrubs and plants grown on the milking platform as part of his grazing rotation, utilising every vertical inch of growth as well.
“Our grazing is tiered, we have vertical and canopy grazing. A cow can reach at least 1.5m high.”
Every paddock fence line is planted out, with the tree trunks protected behind fencing and it’s clearly visible where the trees have been grazed.

Farmer: Gavin & Sheryn Fisher
Location: Te Aroha, Waikato
Area: 74ha (50ha milking platform)
Runoff: 16ha
Cows: 150 Ayrshires, polled, A2
Empty rate: 4%, AI and bulls
Farm dairy: 20-aside
herringbone
Effluent irrigation: 20ha with travelling irrigator.
“If you fold that out, it’s a huge grazable area that you wouldn’t have ever had. So it’s utilisation of the land.”
Not surprisingly, it’s brought a whole lot of bird life into the property and they’ve got native birds that have never been seen on the farm before.
Gavin has a vast array of plantings across the farm, from hedges of feijoas, olives and rosemary to nut trees, fruit trees and native trees.
There is a mix of deciduous and evergreen trees and a lot of shrubs which are cow height to protect the cows in winter from southerly winds.
The species selected are also chosen for what is good for the cows’ diet, such as flax which the cows love grazing on and helps to prevent worm burden.
“When I look at what I’m planting, in the summer you want shade and filtered light. In the winter you want warmth.”
The bigger trees lose their leaves in autumn, which is part of the nutrient recycling system, and it lets light in for the winter months to avoid the farm becoming too cold and damp.
Gavin has planted using angles, so in summer there is only sunlight penetrating half the paddock at a time.
This helps with giving cows ample shade while also keeping moisture on the ground for longer to help with grass growth during the hotter months.

A lot of the trees and plant roots go down many metres further than the shallow rooting grasses, so they are able to pull up more nutrients. It’s adding a diversity of minerals and nutrients to the cows’ diets that the animals wouldn’t otherwise be getting, Gavin says.
“At the same time it’s creating the ecology and habitat I need in my system.
“I try to nurture and foster ecologies and just farm them in a sustainable way. I think that’s a really good food production system.”
The cow is a bovine biological harvester and giving them access to a larger variety of food groups which lets the cows be selective of what they want and need to browse on.
The paddocks contain multiple grass and herb species mixtures. The grass growth curve is more continuous rather than boom and bust and the cows graze
the pasture at a higher residual level, which allows the plants to continue to regenerate and for the cows to benefit from the oils in the soft seed heads.
“I’ve been doing this for over 20 years, these days industry is calling some of what I do Regenerative Ag. Most of the practices I’ve done on this property I got told wouldn’t work but I stuck to my guns and it’s paid off.
“A lot of the stuff I did was to futureproof the family business. It’s working out well and will continue to do so in the future. This farm has fed two families and put the children through their education.”
Gavin grows summer crops and prepares paddocks by using a tine rototiller to create just enough soil-to-seed contact for seed germination. The objective is to stunt the growth of the existing pasture so the crop can establish itself. Gavin does not want to kill off the existing pasture which has been there for 40 odd years surviving adverse weather conditions as the pasture has proven its resilience.
He usually plants a multi-seed summer crop which when established looks more like a food forest for the cows. The plants include sunflowers, buckwheat, rye corn, oats, radish,vetch and plantain to name a few. The crop is designed by layering, the taller species are usually grazed on first, then as the cows make their way through, they graze down to the lower species such as the plantain, so I can get four or so feeds off one crop easily, Gavin says.
“If you want diverse plants to grow you have to have diverse conditions. Trees really help you out there with changes in moisture, shade and heat conditions.”
Gavin’s advice to any farmer wanting to go down the organic or regenerative route is to ensure they do their own research. Talk to farmers who have been doing this a while and check out their land.
“Go and look at someone’s farm and see if their farm matches their talk. Seeing is believing.”
In the back of all farmers’ minds is how they will navigate incoming regulation and how they will stay profitable, so more farmers are looking at organic or regenerative principles.
Farmers seem to be looking at it in increments which feels comfortable for them and introducing some parts to see
what works on their farm, which is a good way to do it, Gavin says.
“I respect people who do their own research or experiments on their farms. I think it’s important for farmers to go see farms where they can see it working. Farmers are really good at looking at pastures and animals and seeing what works.”
Gavin started working on the family farm near Te Aroha 41 years ago and has been planting trees ever since.
“I took a more ecological and biological approach and then I looked at how I could add value by tapping into the market premium.”
The farm has been certified organic for 21 years and was one of Fonterra’s first organic suppliers.
Gavin switched to Organic Dairy Hub Co-op Ltd when the co-operative formed in 2015 and is enjoying the fact that organic farming is the sole focus of the business.
After coming from Fonterra, where the organic programme makes up only a tiny percentage of the wheel, it’s nice to be able to feel more connected to the business and its products, he says.

“There is more of a sense of belonging, when you see your products on the shelf.
“You know all of the Hub farmers and can ring anyone on the board of directors and right up to the CEO. The farmer
directors are also organic dairy farmers so they understand the business.”
Gavin sees the future of organics continuing to get stronger because more people are looking at a reason when they are purchasing food, whether that’s the nutritional benefit, the welfare of the animals or the environmental impact of the farming system.
Gavin has his own brand ‘Off the Planet Organics’ and sells fruit and free range eggs from his 90 chickens, which helps him stay connected to the local community.
as farmers aware of the customers’ needs. A lot of the decisions Gavin made around going organic and planting trees was around being future oriented to prepare for future regulation and changing markets.
“NZ and Overseas Organic regulations will always change or expand. One of my roles as the Organic Dairy Hub Farmers Ambassador is putting some systems in place, driving innovation on farms and looking at making sure we are in front of compliance for new stuff coming out.”
“There is a lens on supporting local at the moment. We are lucky in NZ, we can export but still supply to ensure some produce is held back for the local community as well.”
The spinoff for farmers supplying produce locally is that it builds a good connection with the community. They then have a good understanding of the farm systems used and can trust and trace the produce from that farm, it also keeps us
A lot of organic farmers will probably have a headstart when it comes to meeting some environmental regulation changes. However, the challenge will be how organic farming is modelled with the tools that are developed to measure and set overall national targets.
“It’s going to get tricky, do we fit in the same box as the non-organic farmers? Will the regulations capture some of the things we are doing and how organic farming
“I try to nurture and foster ecologies and just farm them in a sustainable way. I think that’s a really good food production system.’
mitigates some of the environmental impacts? That’s going to be the challenge.”
Leaching is a good example and whether models will take into account trees or topsoil quality on a property.
“If you 3D this place you would see all these roots going down capturing nutrients.
“Soils can be a sponge if they’re functioning properly, When I get rain, it doesn’t run off with the nutrients, the soil is absorbing it and holding on to it.”
Gavin has faded most fertilisers out now and relies on the natural nutrient recycling within his own farming system.
“I’ve never thought it was a good idea to rely on a nutrient coming on a ship from the other side of the world so we can grow food in NZ. Is that really a sustainable system going forward?”
The disruption of Covid-19 and the resulting supply issues, rising prices has brought it more to the fore how exposed NZ farmers can be.
“If I got told tomorrow there would be no fertiliser coming into the country for the next five-10 years, it wouldn’t impact my food production system.”
The way Gavin farms now is different to how he used to. He has gradually eased fertiliser use out and was told he would be mining his soil fertility, however after more than 20 years that argument doesn’t stand up, he says.
As an organic farmer, he doesn’t claim to have all the silver bullets, or that he is not affected by droughts or has no animal health issues, but says “we are less impacted and more resilient from adverse
weather conditions”. Organic farmers are more proactive than reactive. He always has a barn full of organic-certified hay for the feed pinch that could occur, especially in the winter.
If any health issue arises he is always looking at the reason behind it.
“When it comes to issues such as mastitis or bloat, I always look at what has caused that issue in the first place, then I can find the right solution as opposed to just using a remedy to move past it.

“If you had a rock next to your bed and kicked every morning, would you continue to kick it and put an organic Bandaid on your foot, or would you get rid of the rock and save yourself a sore foot, it’s about root causes not Bandaids.”


Gavin explained an example that on a ‘Financial ledger’, doing things like planting your farm with trees didn’t make financial sense at the time. Regardless Gavin went ahead and did it anyway as he saw it as an investment for the future. Now, he hardly has to spend any money on animal health, he has a cash crop off the fruit trees and grows more grass because of the shade provided.
“It wasn’t a waste of money but if you got me to show the figures at the time I was planting them it wouldn’t have convinced people to spend money on planting trees.
“Historically, it has always been about looking at production figures first and foremost. I just think we need a different way of looking at things, setting yourself up for tomorrow and for the generations to come on the land after you’ve gone is just as important.”
With a custom-built iFLOW Rotary Refit.
Frustrated with your old underperforming rotary? Take the pressure off yourself, your staff and your bottom line with an iFLOW Rotary Refit.
Refitting a new rotary into your existing building is by far the most cost-effective option to upgrading your parlour. Plus, the iFLOW is proven for its trouble free-operation and offers the lowest running costs on the market!


Don’t build new. Refit your old rotary with us. Call us today –0800 GEA FARM.
gea.com
Drive dairy efficiencies? We can help.

Organic Dairy Hub (ODH) is now in a position to recruit new suppliers next year with strong interest growing in their new A3 milk powder products.

The co-operative wanted to first maximise the value of existing milk supply before taking on new supply, ODH chief executive Clay Fulcher says.
“We are now at the point where customers are wanting more and we can pull the trigger.”
ODH launched its A3 trademark brand early in 2021; A3 is A2 Beta-casein cow’s milk certified under the United States’ USDA organic standard.
Later in the year the cooperative introduced A3 whole milk and skim milk powders, including lactose-free whole and skim milk powder.
“The products are getting a lot of attention.”
The cooperative’s Ours Truly brand has multiple certification labels on it that make it a premium choice for customers domestically and globally, including food service; A3, (organic certified and A2), nonGMO and grass-fed.
Premium products like this are only growing with people around the world taking more interest in the nutritional benefits of their food and how it is produced, Clay says.
While the jury may still be out on the nutritional benefits of A2 milk, it’s a trend that is highly in demand and where Clay sees all dairy herds in NZ ending up.
ODH currently has 28 farmer suppliers in the North Island producing about 20 million litres of milk.
About half of the suppliers are already supplying A2 milk, with the remaining farmers breeding their herds in that direction. ODH is helping its suppliers transition to A2 milk, and is also interested in helping new suppliers with their transition to becoming certified, Clay says.
For farmers interested in switching suppliers, or becoming organic, ODH has a very accessible share structure and great knowledge and experience within the Hub to assist anyone new to organics to get them on the journey and support them through that process. The farms are also working on a collective A2 breeding programme, Clay says.

ODH processes about a quarter of its suppliers’ milk into their own branded products under the Ours Truly range and sells the rest to partnerships they have with companies including Waiu Dairy Company, Lewis Road Creamery and the
Wellington Chocolate Factory. They also fly fresh milk to China weekly.
The recent launch of Ours Truly Organic Lactose Free powder products has seen huge enquiry domestically and offshore that is driving demand for ODH milk and the need to increase its milk pool.
Ours Truly milk, cheese and other dairy products are also available for New Zealanders to buy online and get delivered to their door in certain areas within NZ, and are carried by a growing list of retailers and cafes.
“One of the huge things for our farmers is having their product in a bottle that their family or friends can buy.”
Being able to offer the brand doorto-door has been a great way to launch and get their name out there, especially during Covid 19, and being able to make it more accessible in retail stores is the next stepping stone, Clay says.
Clay Fulcher - Organic Dairy Hub is ready for new suppliers.
‘One of the huge things for our farmers is having their product in a bottle that their family or friends can buy.’

Trust Alliance New Zealand provides tools and protocols for sharing data, to prove provenance, authentication and food safety as well as biosecurity tracking and tracing.
By Elaine FisherIn a world of emerging distrust fuelled by claims and counterclaims, especially around food products, trust is becoming a key issue, says Chris Claridge, chair of Trust Alliance New Zealand.
“That’s the reason ‘trust’ is part of our name,” Chris says. He is among the speakers at the Primary Sector Marketers Forum in Wellington in February 2022.
“Trading and the exchange of goods is based on trust. Without it, transactions cannot occur. New Zealand as a trading nation must operate at the highest levels of trust possible.”
Launched in 2020, Trust Alliance, NZ’s first national blockchain consortium focused on the primary sector, is described as a change agent for primary industries, connecting participants and providers across the entire primary sector value chain.
“In the 20th century, a brand promise was a shared set of values and principles which underlined a brand. That was communicated by words and imagery.
TANZ goes one step further to brand proof and transparency in order that the brand story is underpinned by evidence, facts and data not just rhetoric.”
The alliance began when a group of like-minded organisations came together to establish a trusted digital infrastructure for NZ producers, growers, exporters, retailers and consumers to easily share verified and trusted data. By late 2021 it had 30 members and was growing monthly.
Chris, who is also chief executive of Potatoes New Zealand, says it provides tools and protocols for sharing data, to prove provenance, authentication and food safety as well as biosecurity tracking and tracing.
“Those who came together two years ago to form an unincorporated joint venture, were interested to see if new technologies could provide answers to key issues facing our primary sector around traceability, data accumulated in silos and the increasing compliance costs in time and money for farmers.
Main
• Simple installation, operation and service
• Designed and made in Israel
• No power or water meter required

• No filter required unless water is very dirty
• High pressure option up to 14bar
• Fully warranted

“Many farmers and growers are providing the same data, increasingly required by the marketplace and importing countries, to several different departments and companies. It’s estimated that farmers and growers can spend between 500 and 1000 hours a year meeting compliance requirements.
“Compliance costs have gone through the roof as each organisation, including government departments, local bodies, marketers and export companies, demand the use of separate information systems.
“Our economic analysis shows that up to one third of the costs of getting produce to port is chewed up in compliance costs at the farm gate. Many of those costs, removed in the 1990s through deregulation, have now been transferred to bureaucratic information interfaces surrounding farm operations.”
Through a series of workshops TANZ identified issues around data integrity, data sharing and data interoperability that, if solved, would significantly reduce cost and friction in the marketplace for all participants. TANZ was established to connect data silos and allow the sharing of data in a secure, trusted and permissioned manner.
Among TANZ’s agri-sector members are SilverFern Farms, LIC, Federated Farmers, Farm IQ, Norwood, ANZCO Foods, EcoDetection and MyEnviro.
Chris says it hasn’t been hard to encourage companies and organisations to share data for the benefit of all. “It’s very much in line with the co-operative model, beyond the farm gate, that NZ farmers are used to.

“Farmers are already digitally connected through websites, apps or other forms of collecting data. Now through our current membership we digitally touch each farm four to five times to create a network of linked organisations.”
The Trust Alliance digital tools and protocols have been built by TrackBack Ltd, a decentralised technology provider which is providing the blockchain technology that underscores the data sharing and interoperability of the TANZ consortium.

TANZ members are able to validate critical data elements including compliance,
provenance, traceability and engage with customers. “Connecting growers with consumers will allow them to tell their grower story and get useful direct feedback to improve customer satisfaction and loyalty.”
Chris says TANZ is not a platform. “It is an enabler. It is like the wiring or plumbing in a building. It works in the background but enables others to operate efficiently. It is just another tool to use and so long as the why and what are clear, how you do it is quite secondary.
“The tech we use now is 30 to 40 years old and emerging technologies like blockchain are the forerunners of what happens next which will include automation of systems allowing computers to talk to each other.”
Chris predicts that in future systems will become decentralised, and individuals will have autonomy while still interacting in data sharing.
The dairy industry is well placed to take advantage of the new world of wider data sharing.
“Dairy farmers share data on a daily basis and measure just about everything. In New Zealand we also have unbelievable talent in the agri-tech space but what we didn’t have was the mechanisms to work in concert together. Now we have the choice to be the architects of our own digital systems, rather than have them designed for us.”
The subject of the presentation TANZ will make to the Primary Sector Marketers Forum in February is “Connecting growers with consumers to tell the “farmer, grower, fisherman” story.
• To find out more about the forum go to: www.brightstar.co.nz/events/primarymkt
• To find out more about TANZ go to trustalliance.co.nz
‘Many farmers and growers are providing the same data, increasingly required by the marketplace and importing countries, to several different departments and companies.’
The New Zealand Story offers a tool kit containing thousands of high-quality images.



 By Elaine Fisher.
By Elaine Fisher.
Humans understand stories better than anything else which is why a well-told, intriguing story is a powerful way to engage consumers, The New Zealand Story chief executive David Downs says.

And NZ has some of the best stories to tell.
“New Zealand’s tourism proposition is around our beautiful landscapes but that’s only part of our story,” David says. He is among the speakers at the Primary Sector Marketers Forum in Wellington in February 2022.
“Internationally people regard New Zealanders as reliable, trustworthy and friendly and during the Covid pandemic, we have seen that globally, the positive perception of New Zealand has gone up.”

Marketers who leverage brand New Zealand as part of their marketing strategy achieve a premium for their products, because of the positive perceptions and emotional responses consumers have to anything associated with the country.
This is borne out by research The New Zealand Story conducts into international perceptions every three months. Research conducted by One Picture in August and September 2021, showed NZ continued to be perceived as progressive, inclusive and decisive by the majority of key international markets including Australia, China and the United States.
However, some markets including Germany, Dubai and Japan were forming perceptions that NZ was isolated, unfamiliar, unprepared, and closed.
David says there is a huge opportunity to leverage the positive attributes the world sees in NZ. However, businesses need to address and combat some hard truths starting to emerge in select markets.
“Being closed in a pre-vaccine world earned us respect. However, with the world starting to re-open, vaccination rates and re-opening strategies are becoming the new measures of success.
“It’s the perfect time for New Zealand’s largest sectors to show the world we’re still open for business. They can leverage the evidence that the world cares about who we are, how we live, and how we treat others. We can see from this research that global perceptions continue to evolve and widen.
“To combat any negative perceptions, we need to highlight the positives of our Covid-19 response, and how that demonstrates the core values others admire in us; our care for people, and our
willingness to make tough decisions to do the right thing.”
Launched in 2013, The New Zealand Story helps companies gain competitive advantage by building a strong, consistent profile for New Zealand in international markets. It is a platform on which other businesses in a wide range of sectors can build their marketing programmes.
The New Zealand Story offers a tool kit containing thousands of high-quality images and information graphics which are free for marketing companies to download to use as part of their campaigns.
That widely used material is regularly updated. “This is part of protecting the brand by ensuring consistent, positive and clear messages about what the brand stands for so that the perception of New Zealand is enhanced.”
David says for New Zealanders, an image of a cow grazing in lush open pasture is nothing special, but it is regarded as remarkable in many other countries where animals are kept in feedlots or barns.
“We have a lot to be proud of in this country. We have an incredible environment and amazing people who are good at growing high quality products.”
While the world generally has high regard for NZ’s primary producers, Kiwis can be hard on them, but David says

his personal view is that those negative perceptions are unfounded. “Without farmers and our agricultural sector, economically, we would be a shadow of ourselves.
“It may not have been the case 50 to 60 years ago, but today farmers are at the very forefront of moves towards sustainability and protecting the land. Their entire livelihood depends on the land. They are in tune with nature and understand and work to reduce their impacts on it.
“When the New Zealand Story takes our stories to the world, we don’t claim we are perfect in everything we do but that we are learning and making good progress.”
Authenticity and trust are becoming more and more vital for both consumers and distributors. The FernMark Licence Programme, launched in 2015 to help promote and protect New Zealand products on a global scale, has become the single most recognised New Zealand symbol internationally, David says.

“It is better recognised than the New Zealand flag or the kiwi symbol.” The programme gives licensees the right to carry the FernMark as a simple way to authenticate their connection to New Zealand and at the same time, leverage the positive reputation associated with New Zealand for their product or service.
David is scheduled to present his address – ‘New Zealand’s brand values, understanding New Zealand’s story being told on a global scale’ on February 22 at the Primary Sector Marketers Forum in Wellington.
• To find out more about the forum go to: www.brightstar.co.nz/events/ primarymkt

the next Silicon Valley for the world.”
overseas. The company was launched in January 2021 as a spin-off from the already established company Autogrow which provides automation and control systems for small to medium sized growers.

WayBeyond, founded by Darryn Keiller and focusing on digital farm solutions for large scale, multi-site farms, grew out of a vision he had for the future of global agriculture.
This vision involved Controlled Environment Agriculture (CEA) and combining advanced plant science with the latest technology in an open ecosystem utilising captured data to provide high yielding and sustainably produced crops. These technologies include A.I. based yield prediction, FarmRoad, a crop management platform, and Folium, a climate monitoring solution.
One of the biggest impediments to further increasing New Zealand’s success and perception on the world stage is often our own mindset, says Kylie Horomia, Head of Industry Transformation for the agri-tech company WayBeyond.

“If we continue to believe that we are a tiny country at the bottom of the world, we will always be that tiny country at the bottom of the world. However, if you flip it around, we are at the top leading the way,” says Kylie, who in February will be among the speakers at the Primary Sector Marketers Forum in Wellington.
Internationally New Zealand, and what it produces across all sectors, is highly regarded and justifiably so. “We do wonderful things, particularly in horticulture and agriculture but New Zealand is about so much more than apples, kiwifruit and dairy products. There’s also a huge amount of innovation happening in the agri-tech sector and Auckland, in fact New Zealand, will be
Competition for talent is intense and the sector offers exciting opportunities which is among the reasons Kylie wants to see more young people involved in agri-tech. “Those in this sector are the new face of agriculture. They don’t look like outdoor farmers but those working in front of computers, with data, coding, web and software design are still in agriculture.
“Many don’t want to be farmers and growers, but they do want to be involved in the industries which help feed hundreds of thousands, if not millions of people globally through the production of good nutritious foods.
“They just have a different role to play by creating the technology to help growers and farmers produce food. Theirs is a part of the agricultural story which never really gets told.”
WayBeyond is an example of the way agri-tech is moving and although it’s based in New Zealand, 98% of its clients are
While the focus for WayBeyond is on crops grown under cover, Kylie says some of the technology the company is developing could certainly be applied to other sectors, including dairying.
“When we released our climate monitoring solution, Folium, we had inquiries from chicken farmers among others, as it is able to detect six different environmental measurements with just one sensor. Digital technology is one of those things where it can cross pollinate across sectors. If it solves farmers’ pain points, then it’s job done.”
When it comes to New Zealand’s performance on the international stage, Kylie says it is important that all exporters, no matter their offering, be it primary products, education or technology, should sing from the same song sheet so that the messages going out to consumers are consistent and engaging. That’s among the messages she will be delivering to the Primary Sector Marketers Forum.
• To find out more about the forum go to: www.brightstar.co.nz/events/primarymkt
Covid-19, or indeed any illness onfarm, could affect your health and disrupt how your team can carry out daily routines.
There are a few things you and your farm team can do to reduce the risk of Covid-19, help stop its spread, and minimise disruption on your farm.
Getting vaccinated is the best way to reduce the risk of Covid-19 onfarm. It helps protect you, your team, your family and the wider community.
Covid could be managed if one of your team tests positive, now is a good time to raise this at your next staff meeting.
Planning ahead will mean everyone understands what to do, and feels protected.
There are also a range of other situations your plan might be helpful in – for example if a staff member has an accident, or if a local disaster strikes and some staff can’t get to work.
If someone on the farm does test positive for Covid-19, the Medical Officer of Health from your local District Health Board will decide whether they can self-
Your farm plan for managing Covid-19 should include:
• how you would cover for anyone who is unable to work - we know Covid-19 can have significant health effects even for vaccinated people
• high risk areas where the chances of transmission between staff could occur (for example morning tea or toilet areas)
If you or another farm team member gets sick, stay home and if you have Covid-19-like symptoms, get tested. Staying away from work helps stop the spread not only of Covid, but of other common illnesses like the flu which can leave your team sick and understaffed.
Your farm team should also be following good hygiene practices, maintaining physical distancing and wearing face coverings where appropriate, keeping track of where they’ve been, and have cleaning processes in place.
If your farm doesn’t have a plan for how
isolate onfarm, or if they need to go to hospital or into quarantine somewhere else.
Your farm will also need to notify your milk processor promptly if there is a Covid-19 case, so they can put precautions in place for their drivers.
Your milk processor will work with you to establish a plan for milk collection.
If the Covid-19-positive person can be removed from the milking shed, normal processes can be followed.
You’ll also need to thoroughly clean and sanitise surfaces where the Covid-19 positive person may have been, and which a tanker driver has contact with.
• how you can reduce the risk of transmission, particularly in high risk areas
• how you can manage staff to reduce the risk of transmission – for example through rostering
• what farm tasks are vital and what can be dropped
• key contact information in case your farm owner, manager or a key team member can’t work.
Once you have a plan then make sure everyone understands how it works in case your farm owner or manager becomes sick, and let any new staff know about it.
DairyNZ has a sample template you can use to develop your farm’s plan, and advice on managing and avoiding Covid online at dairynz.co.nz/covid.

Getting vaccinated is the best way to reduce the risk of Covid-19 onfarm. It helps protect you, your team, your family and the wider community.
There are four pillars to building a successful succession plan. They are: Build a strong business first. Communication with family. Fair comes before equal.
Transfer of ownership and control. The first of those pillars. If you haven’t got a strong business when you are looking at succession, you are not going to have many options to make it work.
So what does a strong business look like? First, it has to have scale. A business generating $1.5 million of income is going to have more options than one half that size. Every business has fixed overheads, regardless of size. The biggest fixed cost is personal drawings. Your drawings are not a function of the size of your business. They are a function of your lifestyle and your own family’s size, stage and age.
Table 1 shows two businesses, one with twice the scale and both drawing $95,000 for personal expenditure. If we assume farm costs and debt servicing are in similar proportion to income, then after tax, plant and machinery replacement and principal repayments, there is a stark difference in the cash available for investment.
In this simplistic example, the business with twice the scale generates $100,000 or nearly 10 times more available cash surplus for investment, thereby providing more options for succession.

So the amount of free cash generated within the business is key, however we should also look at the balance sheet. This is also impacted by scale. The larger the scale, the more borrowing power a business will have. If we extrapolate out the above and make some assumptions, the respective balance sheets may look like Table 2.
Not surprisingly in this example the equity is nearly double in the larger scale business, both with similar debt and equity ratios.
However, the harsh reality is that the larger scale business has a lot more borrowing power. To be “bankable” a business needs to be strong enough to generate enough “free cash” to repay its debt over 20 years. At current interest rates, this equates to around 2.5% of total debt borrowed. Bear with me while I get a little bit technical. To be able to achieve this, the business needs to have a debt to EBIT ratio better than 11. This is a reasonably “modern” measure, and at least one bank uses this as their criteria to assess credit risk (Table 3).
Given the profit and loss of the two businesses in this example the lower scale business is pretty much fully lent whilst the larger scale business can most likely increase its debt ratio to 43% meaning it could potentially borrow another $1.4m. The harsh reality therefore is in this example the lower scale business has very few options. With $4.7m of equity, at 68% of total assets, what would appear to be a bankable business in its current state has
If you haven’t got a strong business when you are looking at succession, you are not going to have many options to make it work, Peter Flannery writes.
very few options to remove capital from the business to allow for succession.
Scale on its own though is no cure-all. A business will not succeed or fail just because of scale or lack of it. It is what you do with your scale that is the key. The above example assumes that other than scale all things remain the same. Which generally is not the case. Management and governance remain the key.
As the business grows governance becomes increasingly important. In boxing parlance, a good big man will always beat a good smaller man. But size without skill is a weak and possibly overconfident combination and is unlikely to succeed.
Other than scale, a strong business needs to be managed and governed at a high level. Scale, particularly significantly large scale can lead to a loss of attention to detail and an increase in waste. So if your income is say $3.0m, and farm working costs sit at 65% and debt servicing at 25% then 90% of your income has been spent, before drawings, tax, plant and machinery replacement. A business in that situation should be focusing on survival rather than worrying about succession.

As the scale of a business increases and as the number of staff employed increases, the greater the need for the owners to have strong employment skills. The ability to employ the right people, develop, train and retain them becomes just as, if not more important, than day-to-day farm management skills.
I often get asked, should we be building off-farm assets? My answer has always been, will it help build a
stronger business? If the business is generating “free cash”, what should you do with it? Most banks will require you to be repaying some principal but what should you do with the rest?
The trap is to lift your lifestyle, and see your drawings lift accordingly. If you are disciplined though, you have two choices. Increase the rate of debt repayment or invest elsewhere. Developing the farm to its optimal level will generally always provide a return better than the cost of interest. However, if the farm is already well developed, what next?
Buying adjoining land or land that adds balance or strength to your existing business has always been a good move, particularly if you are growing from a position of strength. However, buying land “just because you can” is not necessarily the right thing to do. Always understand your “why”. What is your long-term plan?
Buy more farming assets or off-farm assets? The advantage of investing away from farming is that when the time for succession arrives you will have assets that can be sold or transferred without
impacting on the existing farming business. However the two critical considerations for this strategy to be successful are: Understand and be very interested in whatever it is you are investing into, and secondly it should not put at risk your core farming business.
Building strong businesses generally doesn’t happen by accident. You need a clear vision, a robust plan to achieve it and a strong desire to be the best you can be. Know where your strengths and passions lie and invest accordingly.
• Peter Flannery is a Southland and Otagobased agribusiness consultant who has 20 years’ rural banking experience. He started his own company Farm Plan 10 years ago facilitating families and their businesses through a business succession process.
• First published Country-Wide Sheep October 2021.
The harsh reality is that the larger scale business has a lot more borrowing power. To be ‘bankable’ a business needs to be strong enough to generate enough ‘free cash’ to repay its debt over 20 years.The remaining three pillars will be covered in future issues of Dairy Exporter.
Having to fork out for supplementary feed for calves in the middle of a hot summer, when the paddocks are struggling, can be frustrating and expensive. Especially with increasing droughts and changing rainfall patterns forecast for the northern North Island.
Coming up with more resilient pastures and cropping options instead of relying on supplements makes good sense, AgFirst consultant Phil Weir says.

A new six month trial underway, using funding from Our Land and Water, hopes to come up with ‘summer safe’ seed mixes that would be able to handle not just drier summer and autumn conditions, but also wet ones.
Cropping mixes of up to 11 species will be looked at for farmers raising dairy calves. They need to be easy to use with as little labour as possible, Phil says.
Rather than year round pastures, these are single graze mixes that combine crop, cereal and pasture species without any extra supplements needing to be fed out from January through to mid-March, taking advantage of spring rains to get the crops up and running.
Along with farm advisory work Phil also runs a contract grazing business raising dairy beef calves for beef. The trial will be run on his property in the Waikato.
From a business perspective he wants to know if there is any advantage in adding multiple species of plants that grow well in the area instead of monocrops like kale.
Covering the bases: Dr Katherine Tozer says the team will be combining plant species that have different growth characteristics above and below ground.

Does it result in less pest pressure, less weed burden, less spraying, and what are the yields like, he says. “Basically, which one is going to give you the cheapest drymatter.”
The cost of post-emergence spraying is something he is particularly interested in as he’s always been “on the fence” about this type of spraying. He intends to leave half of some of the trial crops without spray to see if its needed at all with multiple species. If not, this could save spray costs and labour. It would also produce lower emissions with less tractor use.
A neighbouring farmer’s dairy calves will be run on the crops. If they are clearly not doing well they will be replaced with older dairy heifers, Phil says.
Ryegrass is not drought-tolerant and is running foul of hotter and drier Northland and northern Waikato summers-autumns. In an effort to combat this and fill in the feed gap, the team will be combining plant species that have different growth characteristics above and below ground, Dr Katherine Tozer with AgResearch says, to make good use of the soil water and nutrients. The same applies to plant material
Crop mixes of up to 11 species are being tested in a series of trials in the Waikato to build pastures safe for wet or dry summers. By Delwyn Dickey.Left: Multi-seed mixes include crop, pasture and cereal species.
above ground, with different growth habits to capture as much light as possible.




Some of the 12 different mixes are straight crop species while others will combine with perennial pasture species and cereals like oats.
Katherine is also keen to see the results of a couple of smaller trials running alongside that will look at how well different species ‘play’ together.
Using plantain, rape, red clover and oats species, small blocks are planted in the different mono-cultures (single species), while other blocks have all the species in different proportions.
If the DM coming off the combined blocks is more than the DM from the monocultures this means they have a positive effect on each other – they’re good buddies and encourage each other. If it’s less they have a negative effect - they clash and need to be separated. This should help Katherine predict how they will grow together compared to when they are used as a mono-culture crop.
Having different combinations of plants helps meet the livestock needs for energy and fibre while producing lots of dry matter.





Having the variety should also counter some of the metabolic issues that can show up in cattle when only feeding on monoculture crops.




Part of the trial also looks at a 12 species mix and a 20 species mix to see if there is any benefit from lots of variety or if benefit will come down to specific species being more important.
At this stage Katherine is more inclined to think it will come down to specific species.
They’re using plants they know will do well in the upper North Island, do well in a grazed environment, and have certain characteristics that will fill that summerautumn feed gap, she says.


* Also involved with the project are Agricom New Zealand , PGG Wrightson Seeds, and Farmlands Co-operative Society.













































Having different combinations of plants helps meet the livestock needs for energy and fibre while producing lots of dry matter. Having the variety should also counter some of the metabolic issues that can show up in cattle when only feeding on mono-culture crops.Hamish Johnstone and Georgia Massie with Agricom putting down seed at the start of the trial.
Despite lawsuits in the United States, and scrutiny in the European Union, glyphosate has no other effective herbicide competition. By Elaine Fisher.
Topsoil lost to wind erosion, the release of soil carbon to the atmosphere and damage to soil structure could be among the consequences for pastoral farming should the use of the herbicide glyphosate ever be banned, AgResearch principal scientist, Weeds, Pests and Biosecurity Team, Dr Graeme Bourdôt says.
“Glyphosate is a very important tool that dairy farmers have come to rely upon for pasture renovation and seed bed preparation for arable crops and maize silage. Herbicides are a key element in no-till planting programmes in the arable sector which allow farmers to protect soil structure and biology and reduce erosion.”
Glyphosate, best-known by the brand name Roundup, is under increased scrutiny in this country where there have been calls for councils to stop using it on roadsides. It is regulated in New Zealand under the Agricultural Compounds and Veterinary Medicines (ACVM) Act 1997 and the Food Act 2014.
Glyphosate is approved for use in the European Union until December 2022 when it will come under review. In the United States, Monsanto, now owned by German company Bayer, is facing more than 9000 lawsuits from plaintiffs, mostly former gardeners and agricultural workers who believe Roundup exposure caused their cancer.
Graeme says although there are no plans to do so, banning
glyphosate in NZ would probably result in farmers reverting to the ‘older’ ways of vegetation control for establishing new pastures.
“This could include herbicides such as paraquat and summer fallows (tilling) with multiple soil structure and soil biota-damaging cultivations (to kill difficultto-control weeds such as docks and buttercup which are readily controlled by glyphosate), topsoil loss to wind erosion and release of soil carbon to the atmosphere.
“The herbicides that were used prior to 1975, when glyphosate came on the market, are mostly still available but generally more than one of them is required to control all the target species and many of these herbicides have medium to long residual activity in the soil and other worrying environmental impacts.”
AgResearch does not have statistics for the use of glyphosate in the pastoral sector in NZ.

“We can confirm that it is an herbicide that pastoral farmers, including dairy farmers, have come to rely upon, particularly for pasture renovation and seed bed preparation. Its broad spectrum of activity against grasses and many broadleaved weeds and its lack of soil residual activity make it an ideal herbicide for removing the existing pasture plants and minimising the need for soil cultivation and a fallow prior to sowing the seeds of the new pasture,” Graeme says.
There appears to be no synthetic chemical herbicide alternative to
‘Its broad spectrum of activity against grasses and many broadleaved weeds and its lack of soil residual activity make it an ideal herbicide for removing the existing pasture plants and minimising the need for soil cultivation and a fallow prior to sowing the seeds of the new pasture.’
glyphosate on the horizon and AgResearch is not working on finding an alternative.
“Our research with herbicides is focused on understanding and managing herbicide resistance evolution in weeds. This research includes resistance to glyphosate along with other key mode of action herbicides used in arable crops and pastures. At this stage only perennial and Italian ryegrass are known to be resistant to glyphosate in New Zealand.”
That research is conducted throughout the country and in each AgResearch campus, involves both internal collaboration (genetics, bioinformatics, data science) and with the Foundation for Arable Research, Massey University, NIWA, Landcare scientists and regional councils.


“Another key focus area for our weed research is non-chemical weed control; options include biological control using insects and fungi, deferred grazing to allow pastures to outcompete certain weeds and cover crops and other projects using advanced technology such as lasers and pulsed micro shocks.
“In addition, we have a substantial internal biosecurity focus with our research. Here we are aiming to quantify the weed risk posed by all 2841 exotic plant species in New Zealand that have either already naturalised locally or widely or are causal garden escapes that may eventually naturalise.
“This is a big ask, but if successful will provide biosecurity managers, for the first time, with the quantitative estimate of weed risk they require to objectively prioritise plants for national and regional weed management,” he says.
In 2018 AgResearch released the ‘Pastoral Sector Weeds Research Strategy’ and since it was written, AgResearch and its industry and university collaborators have been successful in securing five years of funding from Ministry for Business Innovation and Employment and the arable sector to research the extent of herbicide resistance in weeds of cropping farms in NZ and management mitigations.

This research delivers to one of the top three key issues identified in the strategy. The other two top key issues in the Strategy, Internal Biosecurity and Alternatives to Herbicides are being addressed through the AgResearch Strategic Science Investment Fund (SSIF) project ‘Ecology and Management of Pasture Weeds’ with co-funding from some regional councils and from aligned industry-led Sustainable Food and Fibre Future (SFFF) projects.
Graeme says the funding for the AgResearch-led ‘Managing Herbicide Resistance” MBIE project combined with existing SSIF and SFFF funding has enabled AgResearch to retain its unique weeds community of practice team of five scientists and four technicians.

Many New Zealand farmers are nervous that they may lose the right to use glyphosate, considered an important tool in enabling them to grow pasture and food, Agcarm chief executive Mark Ross says.

With the chemical, commonly known by the brand name Roundup coming under closer scrutiny and with the Environmental Protection Authority calling for more information on it, Agcarm commissioned the New Zealand Institute of Economic Research to conduct a report into its use.
Released in early November, the report estimates herbicides are worth up to $8.6 billion to NZ agriculture, with an average impact on output of up to 20%.
and nutrients. An even greater pressure exists with climate change and the need for farming practices to become more sustainable.
If glyphosate was not available, farmers would need to use three to four other herbicides in its place, leading to more tillage and more resources to manage weeds, the report said.
Mark says farmers in Europe, France for example, rely on glyphosate to help maximise their ability to grow more food on increasingly smaller parcels of land.
“In New Zealand, people forget that 40 years ago farmers had to till and plough the land, causing nutrient runoff to waterways and the loss of topsoil along with its worms and microorganisms. They also used older chemicals which were not so effective.
“Regulatory agencies agree that glyphosate, when used per label directions, does not present an unreasonable risk of adverse effects to humans, wildlife or the environment.
“That doesn’t mean that you should be careless with crop protection products. Care is still needed in the use of all agrichemicals as it is for many other everyday substances. It’s important to use them according to label directions - keep them out of the reach of children, avoid spray drift and wear the correct protective equipment,” Mark says.
Agcarm is the voice of the animal and plant health industries of New Zealand.
Glyphosate is a broad-spectrum herbicide that can eliminate nearly all weeds, which many other herbicides cannot. The report says without it, producers would face substantial weed pressure - as weeds compete with crops for light, water

“Glyphosate has been the subject of over 800 studies, all of which have confirmed its safety. It continues to be rigorously tested by regulators in New Zealand and throughout the world, with over 160 countries approving its safe use.
It represents the companies that manufacture, distribute and sell plant protection and animal health products and its mission is; ‘to embrace innovation and drive sustainable food production’.
Glyphosate is a broad-spectrum herbicide that can eliminate nearly all weeds, which many other herbicides cannot.



When Clay and Joy Paton signed a contract milking agreement on a Golden Bay farm, they had carried out due diligence to make sure the figures stacked up financially.
They decided there was no point moving to contract milking unless it returned a profit of $30,000 or more above a manager’s salary, depending on the property. On a smaller property with a salary of $60,000, the contract needed to bring in $90,000, while on a larger farm where a manager may be paid $110,000, they would need a contract that resulted in $150,000 to make it worthwhile taking on the extra responsibilities.
Like so many in the dairy industry, Clay started out on a different career path before finding his feet on a dairy farm. A flair for design at school led him to university to study landscape design but he soon realised he would be sitting at a desk too much for his liking. Looking for a new career path, he escaped with Joy to a three-month contract on a large dairy support block in Central Otago that wintered 800 cows, 800 rising two-year-old heifers and 400 yearlings. He loved it. Joy had grown up with sharemilking parents and the couple adjusted their sights and focused on a future in dairying.
Clay went on to become the country’s Dairy Trainee of the Year winner in 2017 while working on a farm near Nelson owned by Brent and Michelle Riley. The next season they moved their young family – which has grown to three young children - to the Rileys’ Collingwood farm for the 2017-18 season and their plan was to prove themselves in a management role. Everyone knew it was not an easy farm. Pakihi terraces had been developed by the Rileys back in the 80s and 90s from scrub-covered, waterlogged land into dairy pasture. Over the years it had been run by contract milkers and when the Patons took over there was still a lot of work to do to improve pasture and lift production.
The farm was originally milking 540 cows on 180 hectares and producing 920kg milksolids (MS) per hectare. Since then they have lifted production to 1300kg MS/ha mainly through a mix of land development using maize crops, herd improvement and improved water system, while continuing to put 0.7 tonnes of meal per cow into the system through the season. Production has continued to improve and this season they expect to produce 350,000kg MS from an increased land area of 265ha.
The Rileys’ home farm neighbours the dairy unit and that has been amalgamated with the farm to bring it under Clay and Joy’s management.
The alluvial flats on the home farm grow 25% more pasture than the higher pakihi terraces and the expanded milking platform now milks 820 crossbred cows. Three seasons ago they negotiated a contract milking agreement with the Rileys that pays them $1.20/kg MS. In effect, they are paid for successful milk production, without the financial burden of investing in stock.
They also did their due diligence before signing up and say that is too often overlooked by potential contract milkers. They sought help from their DairyNZ consultant, a former ITO tutor, bank manager and accountant, plus numerous conversations with others who had gone through the contract milking process.
Due diligence before signing a contract milking agreement has made all the difference for Clay and Joy Paton. Words and pics by Anne Hardie
“We had good people to talk to about how to shape the budget and the rate we would require to make it work,” Clay says. “A lot of people get caught up with the title and don’t do due diligence.
“There were no secrets and we could do an accurate budget,” he says. “It’s about doing an accurate budget and knowing your numbers and then sticking to that budget.”
Joy says they are lucky to have a good relationship with the farm owner and good communication which enabled them to negotiate a contract rate that worked for them.

“We did our budgets and worked backwards, then went to Brent and said this is what we require to make it work. We’re lucky because we have that relationship.”
Because they had already spent a couple of seasons on the Collingwood farm, they could accurately budget for their expenses as contract milkers, including wages, electricity, motor bikes, fuel and dairy consumables.
Wages is their highest cost by a mile, gobbling up 65c in every $1.20 of their contract – it was 80c in every $1.20 before the farms amalgamated and the business expanded to give it more economy of scale. That 80c covers three full-time staff and two calf rearers. Taking charge of staff at a time of an increasing minimum wage, in an area that struggles to attract staff and competition from other industries through Covid-19 times has been the biggest step from a management role.
Paying for staff has been an incentive to take on more of
the work themselves and Clay typically works 4am through to 6pm from calving through to the end of mating, plus the night shift to check calving cows. The farm has up to 50 calves arriving a day at the peak of calving and Clay does the extra hours to ensure staff are on reasonable hours and to save money.
“We’ve thrived because of genuine work ethic to make it work. But it’s not easy and we work a lot of hours. Because our wage bill is our biggest bill, the incentive is there to do as much as you can yourself.
“It’s important to take care of yourself and family though. It is a dangerous incentive which provides opportunity and growth, but also pushes people out of the industry and can put people in bad situations.”
They have a ‘hybrid’ contract because their budget also has to allow for grazing their own young stock. Until recently they had bought a total of 80 four-day-old calves from Brent to raise, that were then grazed off the farm until they calved as rising two-year-olds and joined the herd under a lease arrangement with Brent. As contract milkers they don’t need to own any cows and their accountant has advised them to be careful buying calves and paying grazing for them because it is a cost and a risk that hasn’t always proved worthwhile for others in similar situations.
Clay and Joy say they have been really fortunate that Brent agreed at the beginning that their stock could return
to the farm to join the milking herd, which removed a lot of risk from the equation for them. It is, again, the bonus of having employers who continually reward them for their hard work.

Purely on costs and risks, they have decided to hold off on buying more stock at this stage though.
“The costs and the losses mean we might as well buy them as in-calf heifers when we need them,” Clay says. “The rearing costs and the cost of losses is so close to buying them as in-calf heifers that you ask yourself, why bother?”
The 80 cows they lease to Brent are replaced if they don’t get in calf which means they have a guaranteed number of cows. While they have a budget to adhere to, Clay says the farm is still a ‘doer upper’ with ongoing work to improve it. There’s fencing and spraying expenses that are now their expenses, but that’s part of the trusting relationship that works both ways between farm owner and themselves as contract milkers.
“It goes both ways and we’re rewarded in the long run by those improvements.”
Communication with the farm owner is also vital for updating contract milkers on any changes to the farm system each year so they can update their budget. It might be a reduction in nitrogen due to the nitrogen cap or a
reduction in purchased feed. For that reason, Clay and Joy say it’s important to sit down with the farm owner at the beginning of each season and get an update on all aspects of the operation. They consider a two-year agreement is ideal as that gives continuity to both parties.
Though they don’t pay for fertiliser, the pakihi soils need a ‘little and often’ approach that means applying a little every 30 days. That’s labour, diesel and wear and tear costs that are part of their contract milking expenses, but they trust their farm owner to invest in the farm which will in turn help their business.
They could have looked at sharemilking contracts, but Joy says contract milking can make good money and there are fewer risks.
“On a large scale, with a good contract milking job you’re away laughing because there’s no risks.”
A fixed contract rate means they miss out on the lift in milk payout, but they are guaranteed their income as long as they stick to their budget.
They have the added incentive of their contract to lift production and to achieve that, they continue to make improvements on the farm, largely through the maize programme. When they arrived at the farm five seasons ago, the worst paddocks were growing between five and eight tonnes per hectare and they have lifted that to about 14t/ha harvested.
Each year they have planted about 16ha in maize, with paddocks recontoured during the process to reduce waterlogging on the impervious soils. To date they have worked and replanted 50ha and this year they have 19.5ha of maize spread over the upper pakihi terraces and lower river flats. A larger portion of it is grown on the lower farm now because they can achieve higher yields from those paddocks and hence more kilograms per dollars spent. That will be harvested and fed out in autumn as the herd gets closer to drying off.
“We’re trying to get 4.5kg down their throats for the last three to four weeks of the season to try and dry them off at their calving weight,” Clay says.
Two thirds of the herd – the fattest cows - are wintered off the farm on another block down the west coast of Golden Bay. It is hilly, exposed land and the cows need the weight on their back going into winter because they can struggle to gain weight there. The lightest third is wintered on grass and hay on the milking platform which has the climate to continue to grow through winter at about 15kg DM/ha.
Wintering the cows better has been one of the factors that has helped lift production to 1300kg MS/ha on the pakihi soils. It is also one of the factors that has helped bring the empty rate down from 14.5% to about 8% for the past two years. Between feeding the cows better, being proactive about animal health including metrichecking every two
‘On a large scale, with a good contract milking job you’re away laughing because there’s no risks.’
594,714+
weeks leading up to mating, checking every cow not cycling and improved bull management, the herd has achieved good in-calf results.
Plus, they have significantly increased days in milk, taking August production from 34kg MS/ha to 78kg MS/ha, while peak per cow production has risen from 1.9kg MS to 2.3kg MS.
The herd has AI for the first four to five weeks of mating, then four weeks with bulls, followed by two weeks with short-gestation dairy bulls. In the past, the farm has bred dairy-beef as non-replacement calves which can be farmed out on the West Coast property but easing beef prices and simplicity of management has prompted an emphasis on dairy replacements where there are better returns.
That new strategy translates to 370 heifers born onfarm, with 160 of those destined for the herd and the remainder farmed on to sell as in-calf heifers. This year they have stretched AI to six weeks to get more heifer replacements to sell down the track. Clay and Joy will continue to rear about 100 Friesian bulls as well as 30 breeding Jersey bulls, with the remainder of the bull calves sold as fourday-old calves or put on the bobby truck.

From calving, the heifers are run with vulnerable cows as one herd on the lower, more productive flats and milked through that shed, while the remainder of the herd graze over the pakihi terraces and slopes. The longest walk for the main herd is 1.7km, leading to the 50-bail rotary dairy. Cows are milked twice a day until Christmas and then go on to 16-hour milkings through to the last month before drying off when they are milked once a day to enable them to put on weight.
In Clay and Joy’s first season on the farm, the dairy was fitted with automatic cup removers and that has enabled milking to be a one-person job. That makes a huge difference for them now they are contract milkers paying for staff.

The meal feeding system has also been upgraded, including a larger silo, which are costs covered by Brent to improve the system that in turn frees up time for Clay. The farm buys in 560t of meal for the season which is fed out at 3kg/cow through spring, 1kg/cow during summer and then 2kg/cow in autumn.
The lane system was also upgraded last year and Brent bought a new silage wagon and tractor for the farm. It is investments like that from the farm owner that have helped build trust in their relationship for contract milking. Each side of the contract is prepared to do their part to not only increase production, but also look after the farm and make it easier to manage.

Canterbury couple Ben and Emma Falconer are making good progress in their current contract milking role but their first foray into the system taught them some lessons. Anne Lee talked to them about their move from farm management to contract milking.

Ben Falconer admits his first move into contract milking was driven more by ego than a solid well-informed plan.
It turned out to be two years of chalking it up to experience for him and his wife Emma and while it’s not something they ever want to repeat, the lessons they learned helped them get on the right pathway with the next job.
“I think the ego of wanting to go contract milking got into my head. I was adamant I needed the title of contract milker and when we got offered a job, I thought that’s what we needed for progression.
“But we didn’t do our due diligence and once we were knee deep in it, we realised the contract wasn’t that good.
At 28, Christchurch born and bred Ben, has been dairying since he left school at 17 - apart from a year spent at Lincoln University earning a Diploma in Agriculture and a short stint in sheep and beef for his practical work.
He’s worked for some leading Canterbury dairy farmers and operations and he and Emma are now in their second season contract milking for Dairy Holdings Ltd (DHL) on a 900-cow farm near Dunsandel.
They’re happy with their progression trajectory and are quick to point out that contract milking can be a lucrative way to build cash and equity when you’re aligned with the right people, have a good contract, as they have now, and are prepared to work hard.
But their experience with their first contract milking job serves as a cautionary tale on being well prepared and doing your homework.
“We survived two years there but only because Emma (a
qualified early childhood teacher) got a full-time job at a preschool.”
It was a small farm – just 240 cows and Ben operated it on his own with help from his trusty dogs during the week and Emma at the weekends.

He’d hoped relief staff would be easy to find due to its location but they weren’t, so months went by without a break.
Opportunities they thought would be there to grow didn’t eventuate.
“None of that sort of thing was written down in the contract and looking back we didn’t ask the right questions –we should have been more specific with those details.
“We didn’t go backwards thanks to Emma taking on her job and there was a lot of learning – good and bad so I guess we got something out of it but there are better ways to learn,” he says.
The message is – do your homework well, Ben says.
Their job with DHL as contract milkers on the 900-cow property sees them receive a set contract payment per kilogram of milksolids (kg MS) produced along with the ability to rear stock but they do share in more costs than just those associated with milking.
Ben and Emma receive a monthly contract payment per kg MS based on 85% of the expected milk production with a washup payment made at the end of the season.
“It means we know what our income is each month so it makes it easier to budget and we’ve also got income over the winter months. That was important in the first season when you’ve got to pay staff and have outgoings over those first couple of months but would otherwise have no income.”
They share in the good times with a one-off payment of $10,000 if payout exceeds $6/kg MS. That’s paid in the season following, providing they’ve renewed their annual contract and remain on the farm.
But they’re protected if something untoward happens to affect production too, with a guaranteed minimum return in the contract.
The nature of the contract means they share in more of the expense side of the budget than a straight contract milking rate.
“We basically provide everything that moves – tractors, wagons, bikes and people.”
But they also pay 20% of several costs.
“The nitrogen costs payment has been reviewed and next year we’ll just pay the full cost of spreading it rather than any portion of the fertiliser.
“DHL has years of data on what these farms cost to run and what they produce and they’re always analysing and reviewing that so you’re going in with a lot of data.
“The contract is very
transparent – it’s all laid out so there’s no surprises - just how the season goes and – well, that can bring its own challenges and that’s the risk you take in being a contract milker.”
Ben says the major drawcard on the contract is the ability to rear youngstock for sale or to rear them and lease them back in to the herd.
“Our aim is to make a profit - an EBIT (earnings before interest and tax) of $45,000 out of the cash returns on our business but we haven’t quite cracked that yet.
“The equity we can make from the stock side – that’s what we’re about to see coming in now and that’s the other bit of the puzzle – it makes the whole picture.
“We have 70 R2s (rising two-year-old) with the bull at the moment that we’ve reared and next season we’ll get a lease return from them to add to the income side of our budget.
Farm owners: Dairy Holdings Ltd
Contract milkers: Ben and Emma
Falconer
Cows: 900 Cross breed
Production: 320,000kgMS
Supplement: 60kgDM/cow budget (fed as required)
Irrigation: Centre pivot – K-lines for corners being installed.
Farm Dairy: 45-aside Herringbone
They get 100% of the bobby calf return and have also reared 40 Jersey bull calves this season for external sale.
The R2s will owe them about $700 each by the time they come into the herd.
Ben and Emma have paid rearing costs that include DHL’s grazing charges once calves get to weaning weights.
DHL has its own grazing properties with no stock bought-in from outside the operation.
“So we make some cash income from the calves we sell, build equity in the value of the R2s and cows as
they go into the herd plus we get the cash income from their lease.”
“That’s what will help make us bankable with whatever we do next.”
The couple came upon the DHL job through a connection with DHL supervisor Mick O’Connor.
“It’s very important to be aligned with who you’re working for and with. Running a system one system might not be for everyone but we talked a lot to Mick and really worked at understanding everything about the contract and the farm before we signed up.”
There had been some tough times last season with Mycoplasma bovis testing due to a long-gone but suspected tracer animal having been on the farm.
They were all clear but the timing meant they couldn’t send calves or culls off and while there was supplement from MPI to compensate, they were down on production and there was a lot of added stress. Last season’s mating went very well though – they increased the six-week in-calf rate by 14% to 78% and dropped the empty rate from 18% to 8%.
“I had hoped the extra cows calving earlier this year would have meant a good increase in milk but the season has been terrible for growing grass.”
The dull, dreary and unseasonal wet days have meant lower irrigation costs though.
“There’s usually a positive for everything somewhere,” Ben says.
He’s had two staff move on since spring – both for progression but it’s meant like most farmers staffing has been stressful too this season and the workload’s been high on those left.
“We’re saving on wages too, I guess, but becoming an employer and taking on the staffing side of it isn’t to be underestimated when you’re thinking about going contract milking.
“It’s a massive part of it.”
There’s increased office time in managing payroll – something Emma does using Smartly –formerly SmartPayroll and then there’s the financial aspects of running your own business –paying GST, managing accounts and monitoring the budget.
They use Xero for their accounts and Ben admits he’s not a great fan of sitting down at the computer.
“When you’re a farm manager you’ve got the farm owner to fall back on but when you’re a contract milker the staff side of it - it’s all on you.
“You’ve got to manage different personalities and make sure people can work together.”
Contract features:
• Hybrid contract with per milksolids payment, guaranteed minimum return and shared bonus during high payout.
• Provide all motorbikes, tractor, feedout wagon.

• Shared costs include:
• 20% bought-in feed,
• 20% nitrogen and spreading, (changing for next season)
• 20% mixed age cow winter grazing
• 100% farm dairy electricity
• 100% farm dairy chemical and rubberware
Ben’s a people person and doesn’t have difficulty communicating and says he learned a lot about treating people well from his former employers Graham and Adele Wells when he was a farm manager.
“It’s about taking an interest in people – they’re not just there to milk the cows.”
Making people feel comfortable and valued is important and it’s something he’s good at with one of his employees nominating him for a monthly DHL award because he’d made them feel like part of the family. Over time the couple’s goals are changing and where they once thought herd owning sharemilking would be the next step, they’re contemplating other options now. The birth of their first child Beauden in October has given them a new perspective.
“We’re not closing ourselves off to any options – the sky is the limit for us and we can go as far as fast as we like or take it a bit more slowly and get some balance back.”
That’s the beauty of the options within dairying, he says.
Based on more than 100 sets of accounts
the top 25% of contract milkers are averaging $97,000 equity growth from profit per year but for the remaining 75% the figure is about $11,000.
DairyNZ farm system specialist Paul Bird says analysis of the accounts over the past three years shows the top 25% are able to retain almost 30% of their income as profit making it available for equity growth.
There is a wide range of contract types from straight cents/ kilogram milksolids (kg/MS) payments to hybrid contracts which are a mix of contract milking and variable order style agreements.
A $97,000 equity growth from profit figure equates to earning about $245,000 as an annual salary because of the savings from living and working onfarm and the ability for the business to absorb some costs, Paul says.
Based on his analysis of contract milkers’ accounts it is apparent there is some advantage in larger scale jobs but they are not a guarantee of greater returns.
Within the top 25% group there was a big range in milk production.
Contract milkers and variable order sharemilkers manage 22% of New Zealand’s dairy herds according to the latest New Zealand Dairy Statistics.
There are 1594 contract milking operations based on the latest statistics and 799 variable order sharemilkers – a total of 2393.
That compares with 1831 herds managed by herdowning or 50/50 sharemilkers.
In the 2017/18 season there were 1848 herds run by herd-owning sharemilkers and 10 years ago that number was 2218.
Contract milking numbers have increased by 154 since the 2017/18 season when that operating structure was first specified in the statistics.
A $97,000 equity growth from profit figure equates to earning about $245,000 as an annual salary because of the savings from living and working onfarm and the ability for the business to absorb some costs.
Drivers of equity growth from profit:
• Scale an advantage but not a guarantee of high profit
• Contract rate alone not a key driver
• Contract rate and stock income combined have greater influence
• Operating expenses a key driver
• Drawings have strong impact on expenses and influence overall profit
Contract rate on its own wasn’t a significant driver of equity growth from profit either but the inclusion of stock income into the equation meant gross farm revenue per kg milksolids (MS) had more of an influence on overall profitability.
On average operating expenses for the top 25% of performers was $1.12/kg MS compared with $1.22/kg MS for the rest, making operating expenses a key driver of equity growth from profit.


Logically, operating profit itself is a key driver with the top 25% earning 21c/kg MS as operating profit compared with 4c/kg MS for the other 75%.
Drawings played a role in that with the top 25% drawing $16,000 less each year than the rest.

The DairyBase data represents herds averaging 560 cows however the true average is 484 cows so it would be ideal to have more smaller herd contract milkers and variable order sharemilkers utilise the DairyBase.



Drawings/kgMS
Equity growth from profit – total $
Drawings is up to you to manage and has a big impact on
Operating expenses / kgMS
Operating expenses/kgMS
Operating expenses / kgMS is a driver of equity growth from profit
total

Equity growth from profit – total $

Contract milking and variable order sharemilking offer exciting opportunities and strong returns for motivated, welltrained people but some aren’t making any equity growth at all.
DairyNZ systems specialists Paul Bird and Phillipa Hedley have just carried out a study, talking to 35 people including contract milkers, variable order sharemilkers, farm owners and rural professionals. They’ve also analysed DairyBase financial data.
That’s allowed them to identify several success factors and actions that farm owners, those they contract to run their farms and others in the sector can take to help create better win:win situations.
“The variable order sharemilking and contract milking business models are one of the key ways of attracting talented people into the dairy sector who will be future leaders and dairy farm investors.
“These businesses provide the opportunity for people to grow wealth proportionate to their skill level and motivation,” Phillipa says.
The research included financial analysis to assess whether contract milking and sharemilking are profitable and
identify any trends in business numbers.

Analysis of DairyBase financials over a three-year period from 2018 to 2021 showed contract milkers and variable order sharemilkers are $32,300 better off financially than if they managed the same farm.
Paul’s analysis has also showed the top 25% performing contract milkers generated $97,000 of equity growth annually from 2017 to 2020.
“Those farmers could realistically be in a position to buy a farm if they save and invest their profits consistently over time,” Paul says.
But some within the other 75% are struggling financially.
Based on their research the pair say the most common likely causes for that include a poorly designed contract in terms of rate and expenses, inexperienced contract milkers coupled with a lack of support from the farm owner.
Contract milkers lacking financial, farm management and people management skills, problems with farm infrastructure and inability to source suitable staff – such as a skilled 2IC were also issues that featured when contracts didn’t go well.
In recent years there has been a trend away from variable order towards contract milking.
In 2021 the Federated Farmers contract milking agreement dramatically outsold the variable order sharemilking agreement, Aaron Passey, Federated Farmers Sharemilker Council chair says.
“Low milk prices in 2015 meant that many variable order sharemilkers left the industry and new business entrants are wary of the arrangement due to the high risk of failure at very low milk prices,” Paul says.

“Contract milkers don’t reap the benefits of higher milk prices, so there is a lost opportunity for them to benefit from the current high milk prices,” Phillipa says.
Some farms surveyed used a hybrid model, which is a combination of contract milking and variable order sharemilking.
The hybrid model generally has similar expenses but shares a percentage of the milk income within a range of milk prices.
There is a range of views on costs with some contracts having only staff and motorbikes and others including electricity, farm dairy costs, and some require machinery supplied. It is rare for feed costs to be shared.
Having a guaranteed minimum return - as in the Federated Farmers Contract Milker agreement - would encourage more people into variable order sharemilking as it would reduce the risk in low milk price years, Phillipa says.
Hybrid agreements were seen by several in the survey as a good pathway to farm ownership because they allow the sharemilker or contract milker to share in higher milk prices.
Drafting contracts to better reward skills and recognise risk will mean contract milkers and variable order sharemilkers are more likely to achieve equity growth.
Exactly what’s included and how the contract is structured will depend on an individual farm situation but if both parties do their due diligence and have a good
understanding of capabilities and risks, they’re more likely to have an agreement that achieves each party’s goals, Paul says.
Every clause should be read and discussed in detail before or at the time the contract is signed so everyone’s expectations are clear.
Owners may be less frustrated if they outline what they expect at the outset and the contract milker agrees.
Owners also need to be realistic of their expectations of a contract milker for the labour they are required to employ.
Large herds with cows having long walks can have staff committed to milking seven or eight hours a day making anything other than essential tasks difficult to achieve,” Phillipa says.
It was clear from the study that some farm owners see contract milkers or variable order sharemilkers as a way to opt out of managing staff and don’t support them enough with career progression.
Avoiding staff employment issues shouldn’t be the driving reason for taking on contracted farm operators as creating successful outcomes for both parties requires input and support from the farm owner.
By developing good contracts through a ‘risk premium’ method to arrive at a fair contract rate and expenses, farm owners will be less likely to struggle to attract skilled contractors in a competitive labour market.
That coupled with a detailed contract with clarity around the terms along with ensuring both party’s goals are compatible and communication is good could help avoid farm owners being disappointed with contract milker or variable order sharemilker performance.
At the same time, it should create more success for
‘Contract milkers don’t reap the benefits of higher milk prices, so there is a lost opportunity for them to benefit from the current high milk prices.’
Paul Bird, DairyNZ
those contracted to run the farm. It was also clear from the survey that there are situations where the contract milker or sharemilker would benefit from further training and development – especially those who are new to the roles.
Phillipa says rural professionals and industry bodies have a role to play in promoting and encouraging people to improve their financial and business skills before starting their own business – for example by undertaking budgeting courses, completing a Diploma in Agriculture or attending DairyNZ’s Mark and Measure course which covers goal setting and financial performance in year one or two of contract milking.




She says it was clear from their research that training pathways for contract milkers to develop their skills are not clear, or the importance of training isn’t always recognised or valued by contract milkers or owners.
So, there is an opportunity for advisers and training providers to give more clarity around which qualifications and pathways are of benefit to contract milkers, she says.
It was also apparent that contract milkers often don’t get good independent advice before signing a contract.
It’s more common for a farm owner to engage an adviser









Don’t let flies take away all your hard work
to draw up the contract or be involved in bringing the two parties together but Paul says contract milkers should get trusted, independent advice from rural professionals who understand the farm management implications of contracts.
A contract is a legally binding agreement. Financially and personally, there can be a lot riding on the success of the venture and there can be a big responsibility to staff too so it’s not a step that should be taken lightly, he says.
Both Phillipa and Paul advised that the contract should be reviewed annually – particularly important in the current climate of rapidly rising costs.
It’s apparent that people aren’t fully aware of the opportunities contract milking or sharemilking offer to achieve high equity gains and contract milkers and sharemilkers themselves aren’t sure about the options to invest and grow their equity. Paul says the sector can do more to promote and share some of the many success stories about people who have progressed and how they’ve grown their funds through a variety of ways – rental investments, investment funds, equity partnerships or herd-owning sharemilking.
Rip into nuisance ies, lice and ticks with the proven power of Ripcord®. Just one easy application provides long lasting protection from nasties around the herd and in the milking shed. And because Ripcord is MPI approved for use in dairy sheds, there is no milk withholding period. Ripcord is the perfect product to use. Don’t settle for fly-by-night treatments. Insist on Ripcord. Visit pest-control.basf.co.nz for more details or visit your local distributor.


Contract milking can be a good vehicle to produce cash returns that you can then invest to grow equity faster.
What falls out the bottom of the budget in terms of profit is more important than your contract rate – understand your costs.
We’ve turned down contracts once we’ve done our homework on the budget and risks so be prepared to walk away if you can see it’s not worth it. Do your homework well when you’re assessing a contract opportunity.
Sometimes you have to follow your gut too – if something just doesn’t seem right, it probably isn’t.

Look for opportunities to rear calves or grow stock numbers to help equity gains or boost income.
Learn how to understand, set and monitor your budget.
Don’t buy the flashest gear but don’t buy the cheapest either – good quality second-hand gear will be worth paying a bit more for.
Put money aside from your first year to pay tax in your second – not being prepared for that can burn you.
Be disciplined and tight on drawings – stay away from personal debt or hire purchase for personal things.
We’re members of Federated Farmers – they can help with employment questions when you’re new to employing staff.
Use a payroll system – we use PaySauce – to make sure you’re getting it right with holidays and hours etc.
Do a DairyNZ Mark And Measure course- you’ll see just what you can do, how you can grow and you’ll learn a lot.

Five contract milking operators give some wise advice on how to make the most money and have the most success running your own contract milking business.
Nick and Kylie Marriott – currently contract milking 900 cows have also been involved in a sharemilking partnership which has bought a farm.Nick and Kylie Marriott: Understand your costs. Jamey Allin.

Jamey Allin and Jenna Wills – contract milking 620 cows in fourth season, going 50/50 sharemilking next season 560 cows.
Contract rate is almost irrelevant – your profit is the most important factor and that depends on costs and whether the production in the budget is achievable. Understand the farm and what is can produce, check the production the farm owner is budgeting on has been achieved before. Do your analysis on what happens if milk production falls short.
A contract where the farm owner pays you an equal split of 85% of target production each month means you can cashflow the winter months.
Contract milking returns are more certain than variable order – income is the biggest variable.
Remember payout can drop suddenly from one season to the next and that can be tough to recover from.
An unattractive farm in terms of infrastructure makes it harder to find good staff – they can pick and choose at the moment.
Keep drawings low, save hard and be prepared to work hard.
Having the opportunity to rear stock can help you build a herd and get income if you can lease them to the farm owners.
Ask a lot of questions up front before you sign anything and do your homework. Read the whole contract and understand all of the budget.
Find out what the contingency plans are – things go wrong, wells blow, earthquakes, droughts – talk about what would happen in some of those situations, have it written down.
Floris and Jen Coetzee - contract milker for eight years, now equity managers on 1100-cow Canterbury farm.

Don’t be too focused on the contract rate – sometimes you can make less money with more income so understand the costs.
Learn about tax – you might not pay much or any in the first year but you need to put aside money because you’ll probably get hit with a tax bill in the second year.
Get a good farm accountant who will go through your budget with you not just do your financial statements, you’ll learn a lot from them. They know the benchmarks and can spot where your costs are high and where you’re doing well.

Do budgets for worst case scenarios to see what happens if you’re say 10% down on production – how far does it have to go down before you’re in trouble?
Do your own GST – you will spot any overcharging someone else might miss and you’ll have a better understanding of costs.
John Duncan – formerly a diesel mechanic, worked on another farm, now contract milking 540 cows for his parents in his fourth season.
Get a good farm adviser if you’re starting out – they act as a gobetween no matter who you are working for and can be the person in the middle which could be a good thing if you’re working for family.
I’ve got a great working relationship with my parents and I think you’d need that if you’re going to work for family.
It’s a good idea to go and do other things before coming back to family operation.
In his initial job as contract milker, he had a straight per kilogram milksolids (kgMS) payment – reduced risk for farm owner. As he proved himself he moved to a more hybrid type contract and gets a percentage payment once payout hits a certain level.

Biggest learning curve is becoming the boss and employing people. Good communication is key – put yourself in their shoes to see it from their point of view sometimes. Be fair.
Use rural professionals such as your accountant with managing the financials and learn from them so you understand it.
Get help with the aspects of running a business you struggle finding time for or don’t enjoy that much – like the office work.
Go to discussion groups and workshops to upskill yourself.
Liam and Lauren Kelly – 50/50 sharemilkers with 670 cows, have contract milked and been variable order sharemilkers.

Pick a good business partner whose values align with yours.
Do your due diligence – when they’re interviewing you, you’re interviewing them too. Sometimes the jobs with the most potential and biggest progression opportunity aren’t the prettiest – look for where you can add value through your skills to increase production.
Have clarity on the owner’s policy on supplement use, nitrogen use and know what they expect will happen if there’s a drought or an irrigator breaks down – what are the contingency plans. Talk to locals, contractors, the vets about the farm and the people – reference check them, do your due diligence. Don’t get hung up on the small things – remember it’s a relationship with give and take.
Be wary of buying the flashest gear – you don’t need your money tied up in depreciating assets. Learn to do things like servicing your own bikes – it all saves money.
A good team makes a world of difference – recruit well. If you’re looking at a new contract milking job be aware poor housing won’t attract good staff.
Take time to listen to your people, learn a bit about them, let the team have an input in to the roster.
Be wary of costs going up rapidly in the last few months – revisit the budget. If you have a fixed rate you’re not benefiting from the high payout but you’re getting squeezed with higher costs. A good accountant will make sure you’re getting the benefits of running your own business in terms of tax deductibility. Be transparent with your farm owners about your goals - if they know they’re more likely to work with you towards them.
Understanding the financials, the details of the contract, the what-ifs and importantly if your goals and values are aligned to your farm owners are all key to the likely success of a contract milking agreement.
DairyNZ extension partner Alice Reilly says having a clear understanding of what’s likely to drop out the bottom of your budget in terms of profit is far more important than the top line contract rate.

Understanding the costs and carrying out a detailed budget is a must before signing on the dotted line, she says.
That will mean digging into the detail of what’s included in the contract and what’s been achieved on the farm before.
“You need to ask plenty of questions so you have a realistic idea of where the costs come from, what they’ve been in the past and what’s likely.
“That means asking for historical costs – asking the farm owner or talking with previous contract milkers or sharemilkers.
“Ask to see the electricity bill for the shed from the last couple of years, find out how often the liners will need to be changed and if they stipulate which ones – that kind of detail can make a big difference to what actually happens compared with what you might assume for your budget.”
Then understand any physical limitations of the farm to achieving predicted milk production – is the budgeted production realistic, how does it compare with previous seasons and is there an opportunity for you to apply your skills and beat the budget?
What is the infrastructure like – the farm dairy,
technology, how many staff will it take to milk, how reliable is the irrigation and how labour-intensive is it, how much pasture renovation is going on or level of cropping?
It’s important to get that level of detail so you can more accurately predict the profit that drops out of the budget.
DairyNZ has a budgeting spreadsheet that allows a contract milking budget to be compared to a farm management role.
Just as for any other farming business, contract milking has a top line – milk income and other income which may be livestock.
It also has expenses which include farm working expenses such as motorbike repairs and maintenance, staff wages, fuel, farm dairy electricity, detergent and any other costs included in the contract.
But the budget will also include costs such as insurance, ACC payments, administration such as accountant costs. Added to those will be interest, tax, depreciation and drawings.
It’s important to understand these additional costs and the effect they have on the final bottom line once all of the costs are subtracted from total income.
The example compares a contract milker with a farm manager on the same farm with the same standard of living.
The contract milker has $58,950 as a cash surplus available for investment.
As a farm manager the risks are lower and the only costs are the personal costs of the contract milker and their family.
But all of the living costs such as drawings, vehicle, fuel, power and phone come out of tax-paid income with much fewer opportunities for tax benefits and to save using business-related discounts.
The farm manager in the example has a cash surplus of $16,101 for investment which gives the contract milker almost a $43,000 advantage.
It’s up to each individual to weigh up the pros and cons of each situation, calculate the benefit and then decide if it’s enough to warrant the additional risk and workload of taking on the contract.
There can be significant financial gains but there are plenty who aren’t making a significant margin and those who aren’t making any headway at all.
Carrying out a sensitivity analysis looking at key factors that could affect the budget is highly advised, Alice says.
What happens if production is 15,000kg milksolids (kg MS) below budget, what happens if the wages costs hike or you’re sharing nitrogen costs and they climb as they have done this season?
Those are the kinds of risks that come with running your own business as a contract milker so they have to be considered.
It’s important to seek advice and run through the numbers with a trusted independent party before signing an agreement.
A rural accountant or farm adviser will be able to talk through costs, know what the benchmarks are and will be able to advise on how to manage the financials, how to pay staff and prepare for tax.
As well as the financial aspect a lot of weight must be put on how well aligned you are personally and from a farm systems approach.
If you’ve been used to higher input systems a low-input system may not fit with the way you like to farm and you could find yourself constantly butting heads with the owner.
You may like input and support from the farm owner on a regular basis and your farm owner is looking to get right away from the farm or it may be you like more autonomy and the farm owner wants to be involved in a lot of hands-on farming.
Having those conversations right upfront is vital to making a successful working arrangement.
Sharing your short and longer-term goals upfront can help set the mindset for the relationship too.
Honesty, integrity and a policy of no surprises on both sides of the relationship is always a good place to start.
“The aim is to have an agreement where both parties feel they’re getting a fair deal and it’s then about delivering on that –having good lines of communication.”
It’s up to each individual to weigh up the pros and cons of each situation, calculate the benefit and then decide if it’s enough to warrant the additional risk and workload of taking on the contract.
A pan-sector Farm Environment Plan that caters for all land use under the same umbrella is the goal of Bay of Plenty catchment group Wai Kōkopu. Wai Kōkopu chair, dairy farmer and orchardist, Andre Hickson, wants to see landowners treated equally and fairly using sound science. Sheryl Haitana reports. Photos by Alan Gibson.
Andre Hickson is chair of Wai Kōkopu, a community-led programme to replenish and revitalise the health of the Waihi Estuary, one of the worst five estuaries in New Zealand.

Bay of Plenty Regional Council has signalled E coli levels in the estuary are 430% above safe levels and need to be reduced by 55%. Nitrogen loss needs to be reduced by 66% and phosphorus by 30%.
The catchment area is 35,000ha with dairy farming taking up 38% of land area, but is estimated to account for 60% of the nitrogen load.
Meeting the new targets will be a big
challenge. Farmers in the catchment are new to any form of environmental regulation and until now haven’t been asked by council for any numbers around leaching or inputs, Andre says.
Andre has got involved in Wai Kōkopu, which has had funding from MPI to create a Digital Pan Sector Land Environment Plan. Andre has four enterprises on his land at Pongakawa; dairy, kiwifruit, avocados and trees.
“If the Government goes ahead and legislates landowners for inputs, I don’t want four farm environment plans.
“I want everyone treated the same, I want the same data collected so everyone
Owner: Pax Hickson Trust (Andre Hickson one of the trustees)
Location: Pongakawa
Area: 75ha milking platform, 25ha kiwifruit
Cows: 280 Friesians
Production: 110,000kg MS, 440kg MS/cow
Farm dairy: 36-aside herringbone, feed pad, DairyNZ System 4, Supplement: 2.2t DM/cow - maize, palm kernel, lucerne, kiwifruit.
Effluent: 33ha irrigated
N fertiliser: 190kg N/ha
Nitrogen leached: 36kg N/ha (56kg N/ha from just milking platform)
Nitrogen surplus: 168kg N/ha from Overseer.
is on the same page, so you can’t play the game or make exclusions.”
Dairy farmers can’t be the only group targeted, he says.
“You have to include everyone in the catchment. We are all in this together.”
Andre’s farm was one of the first of the 15 Wai Kōkopu Lighthouse Farms to have a Pan Sector Farm Environment Plan (FEP) drafted.

The Lighthouse farms will show innovative farming approaches that have a low impact on the environment, to be shared with farmers in the catchment area over the three year programme.
The plans include financial analysis and modelling based on different suggestion options to reduce the farm’s environmental footprint while maintaining profitability (see Table 1).
The FEPs also include a scorecard which scores farms on a variety of areas, from effluent capacity, through to phosphorus
loss to water drinking safety. Andre is passionate that accurate data needs to be collected from farms and good science needs to be behind any recommendations going forward.
want to do it on projects that don’t give the desired outcome.”
The process for farmers to build or develop wetlands on their properties also needs to become easier, Andre says.
He is in the process of working with the regional council to build a wetland on his property, which has already cost $25,000 in consents alone. Other farmers in NZ are prepared to fund environmental restoration and have the same intention to do the right thing, but the process needs to be made easier, he says.


“Why would we do it when there are so many roadblocks and we don’t know the environmental outcome?”
“We challenged Council during plan change consultation - if they want farmers to spend money on it, identify what the science is so we know what our contribution is to the waterways. Test the water at farms.”
“If you make changes you want to ensure you get bang for buck. “If plan changes are dictating that we spend money, we don’t
Too much manual recording is still done by farmers when there is technology that can help, Andre says.
“There is data going into models that probably are not that accurate. Farmers get asked for the data, but they’re busy so they come up with the number from a quick calculation.
“If we rely on manual record keeping, it depends on the day. Was the farmer tired? Were they pressured to find the data
‘If we rely on manual record keeping, it depends on the day. Was the farmer tired? Were they pressured to find the data quickly? If you put shit in, you get shit out.’Left: Tree of Life - Andre’s wife Helen passed away three years ago and he commissioned this sculpture in her memory. Helen and Andre continuously planted trees across the farm for 30+ years. Top: Sharemilkers Lex and Connor Roulston talk with Andre over future plans for the milking platform. Right: Andre would like to be able to combine the kiwifruit and dairy businesses under one farm environment plan.
quickly? If you put shit in, you get shit out.”
The data collected is a NZ Inc story and the various primary sectors need to be communicating and working together, Andre believes. Data collection from farms and orchards needs to become more precise, especially if the data is being used to set regulations. Industries and companies also should be able to share farmers’ data, with farmers’ permission, to keep the data the same across different models.
“Everyone hides behind privacy, but it’s my data. I am a shareholder in Fonterra, Zespri and Ballance. They should all be able to share my data to work together for my benefit.”
It took four generations to clear, drain and develop farming land in NZ, it’s going to take at least two generations to counter some of the environmental consequences of those actions, Andre says.
Andre’s family, the Benners, first settled in Pongakawa in 1896 after emigrating from Clonmel Island in Ireland. Andre’s father Pax and his Uncle John broke a lot of the land in, clearing trees to milk cows. They also planted shelter belts in 1978 and a few years later put in the first 5ha of
kiwifruit. When Andre’s mum died early at the age of 56, he moved home to milk 100 cows on the home farm in 1983 with his wife Helen, where they raised their three children.
Andre and Helen started planting trees on the farm in 1978 and continued planting throughout the years.
Helen passed away three years ago, and Andre had a ‘Tree of Life’ sculpted as a memorial for her in the grounds.
Andre’s Uncle John never had any children so Andre and his brother Paul were able to buy his neighbouring block. Andre, Paul and their sister Janine have a family trust to oversee the assets, which they’ve just gone through a succession process to start splitting up.
“We always had the intention to never sell the family farm, but just before my father died he said you should be prepared to, it frees the next generation to chart their own destiny.”
Succession is fraught with emotion and it took three years to work through the first stage of succession with the help of their lawyer and the bank and another two years to implement it.
The dairy farm has continued to shrink, with more and more kiwifruit planted.

“We just have ridiculous alternative land
use, which turns land values from $35,000/ ha into $200,000/ha.”
The trust employs sharemilkers, Lex and Connor Roulston.
“They were contract milking and they bought the herd in the first round of succession. “They’ve been fantastic. As we take land out, their percentage changes, we’ve gone from 124ha and 450 cows to 75ha and 280 cows.”
The dairy industry will continue to be challenged environmentally by the different drivers from the generation coming through, Andre says. While older generations are maybe more willing to peel back cow numbers and intensity to improve the environmental footprint, young contract milkers and sharemilkers are driven by profit to be in a position to buy dairy farms in the future.
“If we do something for an environmental outcome and a sharemilker’s production comes down 20%, how is that recognised?
“To reduce production for the environment, we also have to convince the bank.”
The industry may need to come up with different models to help the next generation into farm ownership while meeting environmental regulation.
It would be better if primary industries stopped working in silos and came together to tackle environmental challenges in the future, and that includes a farm environment plan to fit all, Alison Dewes says.
There is a lack of consistency across primary sectors when it comes to measuring and modelling environmental outcomes and multi enterprise farmers are left without clear guidelines.
“Our catchment farmers are all asking to deal with it at a one-stop shop, and nobody has come up with that as yet.”
Beef + Lamb uses natural capital as a baseline and still encourages the use of Overseer for nitrogen loss metrics, Fonterra uses a Purchased Nitrogen Surplus (which does not relate to natural capital risks) and the horticulture industry doesn’t work in Overseer and is still catching up.
“It’s difficult for farmers with orchards, dairy farms, and runoffs – which is pretty common in the BOP.”
Land owners, particularly with multiple land uses on the same block, must get confused and frustrated, she says.
They will end up with four or five separate industry plans and disparate calculations to calculate nutrient and emission losses.
At local and central government level there is inconsistency when it comes to dealing with different regions and catchments.
“Councils under the RMA have to protect life-supporting capacity of natural resources for future generations, but across NZ, we’ve had 30 years of catchment degradation.”
At government level, they are coming out with calculators for emissions that don’t even talk to each other, she says. This confuses farmers and advisors alike.
The result of inconsistency is there are pockets of farmers across NZ who have not been trained to farm under environmental limitations, and will need extra help when government regulations are applied, she says.
“There is a real spread around the country for farmers who are fit for providing verifiable data.”
Alison hopes a new pan-sector environment plan being developed in the Bay of Plenty will be able to be taken nationwide, and that it will be easy for all landowners to use to get equal and fair outcomes.
It will also be key when it comes to emissions schemes as well as accounting for nitrogen loads and losses, Alison believes.
If a farm includes dairy, sheep and beef and trees, which operation gets to offset GreenHouse Gases using the plantation areas, riparian zones and trees?
“Will there be double dipping?“
Wai Kōkopu was formed last year and
Alison Dewes hopes a pan-sector farm environment plan will help farmers with multiple land uses cut compliance costs and have a clear strategy to reducing their environment footprint.
sought funding to work with landowners, iwi industry and key community parties to restore the ecological health of a catchment in the Bay of Plenty. The catchment’s three main rivers and streams - Kaikōkopu, Whārere and Pōngakawa –flow into the Little Waihī estuary, which has been identified as one of the worst five estuaries in New Zealand.

The 35,000-hectare catchment is made up of 38% dairy, 5.4% kiwifruit, 12% forestry, 18% exotic forestry. Early estimates appear the contribution from dairy is around 60% of the nitrogen load.
The E Coli levels in the estuary are 450% above what is considered safe for food collection. E Coli contaminants from the catchment need to reduce by 55%, nitrogen by 66% and phosphorus by 30%, Wai Kōkopu project manager Alison says.
Thanks to co-funding from Bay Trust and TECT ($2.2 million), the catchment group is now putting in flux meters for 2022 under orchards to also help validate losses from the horticultural component on the pumice soils.
The Ministry for Primary Industries has funded $1.5m to the Wai Kōkopu programme to work with 15 farmers
Multiple-sector farmers have to work with different environmental guidelines on emissions. It’s time for some common approaches. Sheryl Haitana reports.
in the catchment to promote land environment planning and management, including writing a Digital Pan Sector Farm Environment Plan which encompasses all land use activity.

The Wai Kōkopu Team recently held an industry stakeholders meeting to work together on the pan sector farm environment plans.
Representatives from Fonterra, Zespri, Avocado NZ, Ballance, Ravensdown, Bay of Plenty Regional Council, and other key companies were present at the meeting. The goal is to sign a memorandum of understanding to work together towards a pan-sector plan, to help meet the needs of farmers and streamline and significantly lower compliance costs - for multientreprise farms in the catchment.
Alison hopes ready-to-use, pan-sector FEPs could become a model that is used across NZ once the team has local biophysical data that allows paddock scale mapping.
The FEPs will include economical and natural capital risk assessments and farm system modelling of different farming and land use scenarios to reduce the environmental footprint.
Through working alongside farmers to write these plans, Alison hopes they can showcase to farmers how they can find the ‘sweet spot’, where they can reduce their environmental footprint, while maintaining profitability.
with regulation and expectations on farmers.
“Most farmers want to do the right thing. That is why our catchment group was formed.”
Wai Kōkopu also has a goal to map land use capability down to the paddock level across the whole catchment, which will be useful in the FEPs.
use. In the Rotorua Lakes District we have had 18 years of plan changes, so we have learnt to be fit for regulations.
“We are finding in our second year, farmers are already better at providing data and understanding their numbers more. They are very responsive.”
A key strategy is to encourage large-scale native retirement of riparian corridors, wetlands and steep erosion-prone land to mitigate sediment, phosphorus and E.coli. runoff into the receiving waterways.
“Often farmers end up with a drop in productivity when they go too far chasing a high payout, because their costs go up, their environmental footprint goes up, it puts more stress on them and staff.
“The most profitable and resilient farmers stay in the ‘sweet spot.”
Alison doesn’t get frustrated with the farmers who respond to high payouts by buying in more fertiliser and supplement, it’s the agencies at the top letting that happen because there is no consistency
That will make it immediately obvious which land should be going back into trees or retired to wetlands for example, land that is too steep for >300kg animals on slopes in pastoral agriculture. One of the biggest challenges is that farmers in the catchment have not been used to providing data because they haven’t had any environmental regulation, she says.
“It’s different - coming to a catchment that hasn’t been regulated. I have a small farm in Hamurana, I have changed land
BayTrust’s grant will help Wai Kōkopu get the community actively involved in planting and restoration efforts including weed and pest control. The plan is to develop a local nursery to supply the plants to farmers in the catchment and plant over 200,000 plants a year.
Wai Kōkopu has employed their own microbiologist to do pathogen testing of waterways across the catchment for the balance of the study. The group has also been co-funded by Bay of Plenty Regional Council with a nitrate tester for shallow springs and drinking water.
“We are pretty keen to show what is and what isn’t working.”
‘It’s difficult for farmers with orchards, dairy farms, and runoffs – which is pretty common in the BOP.’Little Waihi is considered one of the worst five degraded estuaries in NZ.
The dairy industry has been in the firing line from environmental groups for years over imports of palm kernel, but governments globally are also becoming more averse to deforestation as alarm over climate change increases.
Large swathes of ancient forest, from the Amazon to Indonesia, are cleared each year usually for logs, farming and plantations. Much of this clearing is illegal. Along with the concerns around loss of habitat for wildlife are the removal or burning of trees which are carbon stores, and damage to soil, especially peat, which then releases both carbon and methane into the atmosphere.
Calls to halt deforestation are getting louder, as seen at the recent COP26 - United Nations Climate Change Conference held in Glasgow last year
where 140 countries, including New Zealand, promised to end and reverse deforestation by 2030.
China, Australia, the United States, Japan and Malaysia - our biggest dairy export customer countries – also committed to this.
Another 28 countries in this group, including the US and UK, also committed to remove deforestation from the global supply chain of some foods and other agricultural products such as palm oil, soya and cocoa.
Commitments made at COP26 are not legally binding - but homeland legislation is. Although it had been in the pipeline for two years, during COP26 the UK passed an environmental law that will levy fines against large companies found to have trafficked in commodities tied to illegal deforestation.
The US looks to be bringing in legislation that would prohibit agricultural products like cattle, palm oil, soybeans, rubber, pulp and cocoa from coming into the country - if their production had contributed to illegal deforestation.
Proposed legislation from the European Commission goes further.
While also centred on restricting products linked to deforestation from entering the EU, they are proposing it covers both legal and illegal deforestation.
The legislation takes note of the products and areas where there has been the most concern around deforestation including palm oil and Indonesia. Rather than relying on certification to say the palm oil production was sustainable, the law would require all companies selling products like beef (including leather), soy, palm oil, timber, coffee and cocoa in the EU market to conduct “due diligence” to prove they are legal and have not caused deforestation or forest degradation.
In 2019, the total size of oil palm plantations in Indonesia for instance was about 14.6 million hectares. Of this only 2.12ha was certified sustainable, according to open source data analysis from Statistica.
New Zealand is the world’s biggest palm kernel importer until recently bringing in over two million tonnes each year, followed by the EU on 1,575,000t. About two thirds comes from Indonesia and a third from Malaysia.
Could this all turn to custard for dairy using palm kernel in the future, if foreign restrictions continue to tighten up?
Phil Houlding, Ministry for Primary Industries’ director of international policy downplays concerns over any increasing aversion to deforestation having possible impacts to imports of palm kernel, or this country’s use of it as a potential problem
for our export markets in the future. Rather than a product, palm kernel is a by-product of a crop grown oversees, he says.
“It is estimated that PKE comprises approximately one per cent of the palm plantation revenue.

“Imports of palm kernel expeller are already falling. PKE imports peaked in 2018 and have fallen 17% by volume since then. In the year ended June 2021, import volumes were nearly 1.8 million tonnes.”
If some of the shine is already coming off palm kernel, what advice or research is out there for farmers thinking of moving away from it or wary of putting all their supplementary feeding “eggs” in one basket. For his part Houlding doesn’t think it’s likely the country would be able to move away from some form of imported supplement, with palm kernel a good option providing a high fibre and energy supplement for ruminant animals, such as dairy cows.
“It helps farmers mitigate animal welfare risks, providing a feed buffer against drought, floods and other climatic events. Often when drought affects large swathes of the country – like we saw in early 2020 –
all home-grown feed can be affected.”
But the heavy reliance on supplements including palm kernel every year, during the hot dry months as pasture struggles is already concerning some farmers.
Those concerns will likely be reinforced by palm kernel prices sitting at about $400/ tonne. Covid-19 is causing staff shortages on the plantations and freight prices have tripled during the last 12 months. Suppliers don’t see this price easing in the short term, and an end to Covid-19 is nowhere in sight.
Northern farmers are not the only ones worried about being locked into a system that will likely see them buying more and more supplementary feed as the north gets not only warmer and drier, but the dry spells last longer, with droughts more common.
The need to start building resilience into farming operations to cope with increased extreme weather events in the future, particularly drought, was behind a recent
call-to-arms for adaptation in primary industries from the directors of several groups in the government funded National Science Challenges.
Set up in 2013 this group looks at tackling various science-based issues and opportunities in New Zealand’s business landscape.
Planning to adapt to intensifying drought conditions in rural areas must start now, led by regional councils, industry bodies, and central government, they say.
“People who farm will have less flexibility and more constraints in a future of intense and frequent drought, making long-term planning increasingly challenging. This could trap people who farm in a crisis-response cycle where decisions are made ‘just in time’, creating vulnerability in farming systems.”
But funding can be short on the ground when it comes to innovation and changing systems as Northland dairy farmer Graeme Edwards found out in his recent foray into using banana plants for summer forage and for dairy effluent uptake.
The exercise has left him disillusioned. (See page 70).
The team that took on Graeme’s miniplantation was able to tap into funding from Our Land and Water - part of the National Science Challenges (above) - who fund about 15 various projects around the country each year, through the Rural Professional Fund.
Imports of palm kernel expeller are already falling. PKE imports peaked in 2018 and have fallen 17% by volume since then.A palm oil plantation on cleared tropical forest. Could legislation aimed at ending deforestation include by-products like palm kernel in the future?
While some projects are ‘shovel ready’ and give results that can quickly bring about positive changes in management, for others the amount of funding only stretches far enough to see if an idea has enough merit to be worthy of further research – as in Graeme’s case.
Our Land and Water also funded projects last year featured in this issue of Dairy Exporter on bore water, barriers to diversification, and trees in dairying.
They have two funded projects on the go at the moment, that deal with reducing or ending supplementary feeding.
A multi-species summer safe seed trial is well underway and being overseen by AgFirst consultant Phil Weir and Dr Katherine Tozer with AgResearch (See page 38) on finding resilient dry summer pasture/cropping for dairy calves.
The other is a largely desktop data analysis looking at moving to zerosupplement dairy systems in the event the dairy industry stopped using imported supplements.
Current drivers for dairy farmers continuing to import supplement, considerations they account for when purchasing, and how farm operations would change if imported supplements ended would be looked at. The payout needed to make these alternatives economically viable is also part of the package, along with looking at other possible alternative feed sources like food waste.
With the amount of supplement being imported could the country even produce enough home-grown replacement supplements like maize, with the amount of suitable land available?
Still in its early stages Sean Nixon from Agri-Concepts has taken the project under his wing until the final team is confirmed.
Concerns over reliance on imported feed and its increase to farm working expenses was behind a three-year trial run by the Northland Dairy Development Trust in conjunction with the Northland Agricultural Research Farm at Dargaville, ending in 2018.

The trials compared two farms using all
home-grown feed (grass only and cropping) with one using imported palm kernel supplement.
They showed grass-only farming profitability, when associated costs with supplementary feeding and cropping were taken into consideration, was similar or better than the palm kernel option on normal weather years. But clay-based soils on the farms during a wet late winter/ spring saw the palm kernel farm a clear winner that year, with cropping on clay discounted for the future.
Another three-year trial followed looking at production and profitability between farms on grass-fed only, palm kernel, and palm kernel plus other supplements. The worst drought in 100 years fell in the middle of it.
Averaged over the three years, when milk prices were low, under $5.86/kg milksolids, the grass-fed farm was the most profitable. When the cost of palm kernel is at the levels they are now profitability on the grass-fed farm would only be slightly down from the palm kernel farm. Should the palm kernel per tonne price rise to $500 the grass-fed farm would be most profitable. Full reports/results on these trials can be found under Past Work on https://nddt.nz.
For some farmers the palm kernel supplement debate is moot as they don’t use it anyway, like state-owned farm Pamu.
“We used to use a lot of PKE but that’s been phased out for four or five years now,” says Matt Johnson, head of farming for
Trials comparing pastureonly and palm kernel dairy systems have been held at the Northland Agricultural Research Farm at Dargaville
Pamu’s dairy operations, with an accompanying reduction in stocking rates. Their systems sit in the 2-3 production systems range with DairyNZ, he advises, instead of at level 5 where some were.
This sees grass and maize silage brought in when needed along with small amounts of concentrate like distillers dried grains (DDG), and on the West Coast and Canterbury farms they use barley grain grown in the Canterbury region, although it’s not a big part of their operations, he says.
Winter grazing and summer crops are also used in different areas.
As far as profitability goes Pamu benchmarks its performance each year across finance, animal, people and environment against DairyNZ, and Baker Ag and their BFM groups - “and we’re comparable”, Matt says.
Other farming groups that steer clear of palm kernel are organic and regenerative farmers.
Northland and northern Waikato are getting warmer and drier. Farmers need sustainable changes to farm systems, so they are fit for the future, says dairy farmer Graeme Edwards. Back in 2018 after a suggestion from their son Paul, a farm systems scientist with DairyNZ, Graeme and Carol Edwards planted up a plot of banana plants adjacent to their dairy effluent pond. They ran trickle irrigation lines through the rows of 65 stems so they could be fed with effluent from the pond.
Graeme was hopeful the plot of Misi Luki bananas could be used to evaluate the possibility of growing bananas as a new summer-autumn forage crop for northern dairy farms and potentially become a more sustainable option for the recycling of dairy effluent.

His efforts to kickstart the conversation around bananas in a dairy system left him
frustrated. While there was strong interest from media, there was little practical research help or guidance from industry or otherwise. Funding was eventually sourced from the Our Land and Water Rural Professionals Fund, and Dr Warren King and Grant Rennie from AgResearch were able to get some research underway.
Now well into his 60s and running three farms, Graeme feels bananas have the potential to provide significant benefit to farming in the north. He is hopeful the results of the study, showing the project has merit, will act as a catalyst for action.
When Warren and Grant had a look at the mini-plantation, the banana plants were nearly two years old and towered over Graeme and Carol. Some were sending up the first stems that would flower and produce fruit.
As the north warms, one dairy farmer is looking for expertise to turn bananas into a future forage crop and a more sustainable effluent cycling system. Delwyn Dickie reports.Bananas thrive in the heat and dry of summer and autumn.
Although there is potential for the plants to produce saleable fruit, the focus of this research was on measuring growth, uptake of nutrients from effluent, and the nutritional content of banana stems as forage for cattle.

Cutting off the main stem of a young plant to make the plant bulk out is an old gardening technique, used in this research to push smaller and outlying stems to grow faster and encourage more new stems to grow. It was meant to approximate what might be left behind after a previous season’s harvest or grazing.
The bananas proved to be more than up to the challenge of some serious hacking. In September 2020, 15 palms had their main stem cut out, some with a forming spike that would have eventually become a flowerhead, along with some other stems of varying heights before being left to regrow.
Compared to 15 other plants that had been left uncut, by January there wasn’t a lot of difference in the final number of stems. All had grown more stems. The cut bananas hadn’t produced greater numbers, although they did grow faster and had regrown to their original height.
The fastest growth came from stems cut out that hadn’t yet started to produce what would eventually be a flower spike, and these shot up to over two metres high by January.
Two plants were also cut down completely on Graeme’s suggestion in January, as if they had been fully grazed. By the end of June these had also grown back to 1.5m.
Estimates of drymatter (DM) from the stems and foliage were taken for cut and uncut plants in September, December, January and June. This saw the uncut plants go from an estimated 6.8kg DM/plant in September 2020 to an estimated 15.9kg DM/plant by June 2021.
A typical banana plantation such as those grown for fruit rather than foliage in Queensland, Australia, has 1600 plants per hectare. For Graeme and Carol’s plantation this equates to 14.6 tonnes DM/ha. At 2000 plants per hectare, also common for some varieties, this could be substantially higher, especially as their palms are still quite young.
The cut plants bulked out from 3.2kg DM/plant to 14.6kg DM/plant in the same time frame, giving an impressive 18.4T DM/ha with the strongest regrowth from the middle stem. The biggest growth spurt happened between December and January when the cut plants increased their DM by 75%, leaving the uncut palms behind with around 40% increase.
Regrowth is impressive, especially as it came in
the heat of summer when soil was dry and pasture might be starting to struggle. But how much of a toll the rapid regrowth has on the plant’s future health and longevity, if it is subject to this onslaught every summer remains to be seen.
Graeme had heard of banana plants being fed to cattle in Queensland. Although not part of this research, he had been throwing the cut plant scraps over the fence to his cows. Initially they seemed a bit uncertain but were soon happily devouring, leaf, smaller stems, and fruit.
While they may have been tasty, did the plants have any food value as a forage? Overall, the bananas showed potential as a suitable feed crop for cows, with digestibility similar to various silages.
Using near-infrared spectroscopy (NIR) on the cuttings along with some ‘wet’ testing showed crude protein was low – like summer pasture in the leaves, with the stalk even lower – like maize silage.
Neutral detergent fibre content was low in the leaves, like spring pasture, with the stem also low, like turnip bulbs (low fibre is good for dairy cows).
With a couple of boxes ticked as a forage, then came testing the nutrient uptake from effluent.
Graeme ran dairy effluent to the banana plot regularly over summer, although volume applied was not measured. In June, soil samples were taken at four depths to see how minerals were moving through the soil profile. This showed no unexpectedly high levels of nitrogen or potassium.
Warren and Grant see the banana forage and effluent uptake concept as having merit and being worthy of more research.
There also appear to be some valuable opportunities. While there is some literature on feeding banana fruit to animals, there are very few places in the world where banana stem and leaf is fed to livestock and very little published work.
“The only work we could find was a tiny little study in the Canary Islands where someone was feeding banana stems to goats. So this is not a common thing to feed stem and leaf to ruminants let alone dairy cows,” Warren says.
The next step would be to do more research with animals and a closer look at the nutrient uptake and cycling.
While Graeme was happy to feed his cows with the plant offcuts and scraps, and the animals seeming to enjoy them, Warren emphasises that this was not part of the trial.
Warren says this trial has been useful to check for “red flags” before testing on animals, which requires significant research funding. “We discovered none.”
Participants: Northland dairy farm with a small herd
Project team: Warren King, Robyn Dynes and Grant Rennie (AgResearch); Graeme Edwards (Kahurangi Farm)
Report: Bananas on Northland dairy farms (ourlandandwater.nz/ RPF2020)
Project aim: To investigate whether growing bananas on Northland dairy farms has potential to increase the economic and environmental sustainability of the dairy enterprise by measuring plant growth, uptake of nutrients from effluent, and the nutritional content of banana stems as forage for cattle.
• Growth surveys on an established banana plot over nine months to determine the timing, growth rate and dry matter (DM) content of leaves and stem.

• At 1600 plants per hectare, regrowth of cuts plants produced 14.618.4 tonnes DM/ha.
• Neutral detergent fibre content was low in the leaves, like spring pasture, and low in the stem like turnip bulbs. Soluble sugars were moderate in the leaves, and high in the stem
• Further work could look to see if the data stacks up if stems and leaves are used for forage.
There is potential for the banana fruit to become a saleable crop.
An escalating lameness problem on Owl Farm came to a head in March 2020 with 34% of the herd identified as lame over the course of the season.

The number of lame cows had been growing over the previous couple of seasons, and it was causing concern due to its impact on animal welfare and productivity. This prompted the farm team to instigate an in-depth investigation into the issue. Since then, actioning a programme of changes has turned the situation around.
Owl Farm is owned by St Peter’s School Cambridge, and is also a demonstration farm, which means the process for releasing investment funds is more involved than for a typical farm, with a detailed justification required before the management committee will give the green light. However, this does mean the
process they use to investigate issues and opportunities is rigorous and generates strategies that other farm businesses can use as well.
The initial step involved getting a handle on the financial impact of the issue.
DairyNZ has developed a tool to help with this process, the Lameness Cost Calculator,

which is available on their website. The calculator indicated that there was the potential to gain $57,000 from tackling the problem.
Next, they engaged the services of Healthy Hoof Provider, Bill Hancock, from Cambridge Vets. Healthy Hoof is a programme administered by DairyNZ
which aims to help farmers to get on top of lameness problems through following a structured process, with the assistance of a trained professional.
After discussions with Hancock they set up a white board to record the incidences of lameness, which hoof they occurred in, and any treatments used. After looking at the recorded information they concluded that the majority of cases were due to white line disease.
“White line is generally a disease of cows under pressure,” Hancock says. “They are either having to push forward out of that pressure, on the yard, the raceway, or feedpad, or back out of a situation. They can potentially get white line disease whenever they have to turn, push, or compete.”
They also installed a GoPro camera on the roof of the milking shed to record footage of cow behaviour on the yard, as well as how the milkers managed cows during milking. The footage was revelatory.
It was clear that having all the cows in each herd entering the round yard from the back and filling up both sides was causing the cows on the right hand side of the yard, behind the gate, to turn around 180 degrees before they were able to move into the free space on the yard. As a result, they decided to place the backing gate in the middle, so that cows still entered both sides, but the backing gate only took up the space behind the cows on the left hand side that were already facing towards the entrance.
This gave time for the cows on the right to turn around and follow the backing gate around before being followed up by the second backing gate. The cows were less crowded, had time to turn to enter the platform, and cow flow improved.

A mirror was also installed above the pit so milkers could see the yard without going up the steps to look.
“Going up the steps to see what was happening had the negative effect of
entering the cows’ flight zone,” says Tom Buckley, Owl Farm Manager.
“Milkers can now look in the mirror instead and this drives when they use the backing gate. It is much better if cows are trained to enter the platform themselves, rather than being pushed in by people, as that interrupts cow flow. We also have a timer and a buzzer on the backing gate so it doesn’t get left on too long, or push them too hard.”
Any signs of lameness are managed proactively, with Buckley’s homemade hoof blocks used to treat any white line affected hooves where the disease isn’t on the heel. Focusing on treating issues early helps to ensure cows spend as little time as possible in the lame cow mob.

Well-designed handling facilities make a big difference as well.
“Having good facilities, with a roof and good lighting, is important as it makes it safe for the cow and the operator,” Buckley says. “And it makes it easier, which means

‘They are either having to push forward out of that pressure, on the yard, the raceway, or feedpad, or back out of a situation.’
people are willing to get cows up early for treatment. The vet is called out for more complex issues – this is also a good opportunity for staff training. They can learn about treatment, trigger points, when it is necessary to call a vet in, and how you can manage and record lameness.”
The final step in the programme of changes involved assessing and improving the race infrastructure. First, the team divided the races into priority areas, after looking at their current state i.e. gradient, trees, and drainage; and the amount of traffic they handled e.g. races near crop paddocks were high traffic zones, and some sustained more vehicle traffic than a typical farm because of Owl Farm’s demonstration role. Then the races’ issues and their remedies were identified.
The changes made a notable difference. “It takes the cows about eight minutes to get up a hill that used to take 40 minutes,” Buckley says. “We budgeted around $30,000 of capital input, with some additional spend year-on-year for maintenance. We were also able to plan out three years in advance.
“When changes couldn’t be made immediately we problem-solved. For example, the slopes in and out of the underpass were getting worn away quite quickly in spring, and contractors were unavailable at the time to come and fix them, so we used AstroTurf to reinforce them.
“This was really effective, and easy to wash, with any flowoff getting collected in the sump. AstroTurf was also effective on the areas getting wear around the feed-out areas on the races and the junction between the race and the yard.
“It’s important to proactively tackle challenges by watching cow behaviour and identifying the possibility of issues.”
The end result of the whole process has been highly satisfactory, with a drop to 15% lameness in the herd in the season following the programme implementation.
Even though the start of 2021-22 has proved challenging, with 599mm of rainfall to mid-November (compared with 420mm last season), the changes have ensured that lameness continues to trend lower than the past two years. The team isn’t resting on their laurels though, as their ultimate goal is to reduce lameness to below 12% annually.


It has been a really good season so far with regards to mastitis in the herd – the bulk tank cell count is 21% down on last season and the clinical cases have been few and far between in the milkers. As I write this, the bulk tank average for the season to date is 84,000 cells/ml and currently the daily pick-ups are around 69,000 cells/ml.

We are still learning every day about mastitis dynamics in the herd, and have made some interesting new observations this season. The baseline cell count for the herd sits between 60 and 70,000 cells/ ml this season and we know when it goes above 70,000 that there is a mastitis case, so we use this generally as our trigger to strip the herd at the moment.
Stripping the herd is a pain in the arse for a lot of people, and it is no different here. In this herd (260 cows OAD) it generally only requires a solo milker at this point in the season. Stripping the herd requires an extra labour unit in the shed, it adds about 20 minutes to the milking time which is a nuisance because we are first on the AB run, and it usually means a new red cow out of supply for a few days.
We have observed something interesting this season, with running a lower than usual cell count – mild E.coli mastitis cases are more readily detectable, and interestingly they are frequently cropping up in cows that have been on heat in the last day or two.
A normal, mild E.coli mastitis case tends to bump the cell count up to around 85,000 cells/ml (bulk tank up by 15 to 20,000 cells/ml) and within two or three days the cell count is back down to baseline again. By the time we have bulk tank cell count in on daily pickups, then have stripped the herd the next morning and found the cow, she is well on the road
to recovery, and may only be out of supply for one milking, not needing more than a shot of anti-inflammatory as treatment. The Strep or Staph cases we see tend to put the cell count up to 110,000 cells/ml (up by about 40,000 cells/ml) until the cow is out of the vat.
And so it was that the cell count yesterday was 85,000 cells/ml, and the herd was stripped at milking this morning. It was my job to strip the herd – and I’ll be honest, it’s not my favourite job – I tend to get cramp in my hands after a few rows which makes the job physically uncomfortable. So I really thought I’d struck it lucky when on just the second cow in the first row, I stripped clots in the front right and found the clinical case.
As is always the temptation – I keenly suggested that perhaps we didn’t need to bother with stripping the whole herd today seeing as we had found our clinical
Top: Milk samples ready for culture.
Below: Milk Culture plates at 20 hours showing no growth and Strep uberis.

case. The suggestion is made so we can have an easier milking, but as we always do, we carry on and strip the whole herd regardless. And as usual, there is a lesson to be learnt from resisting the desire to take the easy way out. Why do we bother?
Well, we carry on, the second row is being stripped, and the fourth cow in the row has clots in her front left, another clinical quarter! So not just one, but two clinical cases.
The fourth row is being stripped, and the sixth cow in I strip blood from her back right quarter. She has clearly had a big knock to her udder and is bleeding into the quarter. Strawberry milkshake anyone?with that amount of fresh blood, it is lucky she was found prior to being milked into supply.
This demonstrates the lesson for why we always strip the whole herd, even if we feel like stopping after finding one clinical cow and having an easy day.
All our clinical cases get milk sampled and cultured – we culture them ourselves using our own cheap, basic system. The two clinical cases are treated with an antibiotic tube and an anti-inflammatory, while the cow with bloody milk just gets an anti-inflammatory. After we have the culture results, we review the treatment plan and decide whether any changes are needed.
Later that day we see the bulk tank cell count has risen to 109,000 cells/ml which fits with finding the two clinical cases that morning. My bet is on two mild E.coli cases and nothing from the trauma case.


It takes less than 24 hours to get a culture result for the cows. From the three quarters milk sampled, the results were –no growth from the cow with the bloody milk, and Strep uberis from the other two clinical cases.
The cow with blood is milked out of supply until her milk is clear. She gets antiinflammatories for pain relief as her only treatment.

The two Strep uberis cases continue treatment with intramammary tubes for a total of three days. And the bulk tank cell count drops back down to 74,000 cells/ml. Job done.
• Lisa Whitfield, is a Manawatu production animal veterinarian.


PETA Zinc Dispensers accurately dispense zinc sulphate in drinking trough water providing the most efficient, economical way to prevent facial eczema. Developed by agricultural scientists at Ruakura Research Centre, the correct amount of treatment is dispensed per-animal per-day.

e in onomical eczema.


ural mount of d ough and

24 hr & 48 hr models available. Simply place in the trough and the job is done.





Purchase a PETA Dispenser from your local rural supplies store or veterinarian.







nser TA m your plies narian.
The efficient, economical way to healthy animals. www.peta.co.nz
It was my job to strip the herd – and I’ll be honest, it’s not my favourite job – I tend to get cramp in my hands after a few rows which makes the job physically uncomfortable.Bloody milk found while strippng the herd.
Five rural professionals aim to fill a gap in the farming industry through their company AgriLeaf Ltd, providing skilled relief staff for all aspects of farming.
By Alex Lond.Aback-of-the-envelope idea resulted in the beginning of a successful company for five ambitious farm workers in South Waikato.

After the first Covid-19 lockdown in 2020 saw the end of many casual farm workers’ jobs, they realised that as a relief or contract worker operating alone in the farming industry you were vulnerable to situations out of your control. And so AgriLeaf Ltd was born, with a diverse range of skills behind them aiming to combat the lack of experienced casual farm workers in the industry while creating a supportive team environment for others.
In the year since the company began, the team have already provided a range of relief work including fencing, yard work, lamb rearing, lifestyle block assistance, consultancy, short and long-term management roles and are now looking to expand into milking.
“We all lost our jobs during the first lockdown, because the law classed us as non-essential despite all our farms desperately needing seasonal workers. It was too risky for them to employ us and that was the case everywhere, none of us could find work,” Lachlan Paine says.
After five years working for Ravensdown, Lachlan decided it was time for change. After a stint overseas with his now fiancé and fellow AgriLeaf shareholder Lucy Aston, they both returned and started casual work after years in full time roles.
Lucy’s post-university experience involved a lot of practical farming roles, and after experiencing lambing in England and Scotland, they both saw the opportunities contract lambing roles in New Zealand presented. Sheep milking was becoming more popular but finding

workers who knew both dairy farming and how to work with sheep was proving difficult.

Diane Karaitiana-Bryant started working for Taupo-based sheep milking farm Spring Sheep Milk (SSMC) as a casual before they converted in 2015. Growing up with her dad as a shepherd and her mum a wool handler, working with sheep was very much in the blood. Before SSMC she worked on multiple farms all over the country and often crossed paths with Lucy and her twin sister Hannah.
Through conversations at work, they started to see how casual and seasonal labour was in high demand everywhere they went, and after Lucy and Lachlan joined Diane on Spring Sheep to help with lambing, an idea started to grow.
“We were all working independently developing our own skills so that we could complete most farm tasks, but by working together we realised we had a combined knowledge of over 50 years with a range of experiences and backgrounds,” Hannah says.
An Ag Sci graduate, Hannah Aston took on a couple of rep roles postuniversity but after two years she decided that she wanted to gain practical experience. After a stint working for Lucy on a dry stock farm in Taupo, Hannah decided to train as an artificial insemination technician (AB tech). Finding her calling, Hannah says she thoroughly enjoys the precise, organised work that she completes as a tech while the seasonal style allowed her to continue working in other areas for the rest of the year. Along with her partner Josh Oden, they make up the final two components of the AgriLeaf team, determined to make a difference in the farming industry.

“I employed Lucy previously as a casual when I was stock manager on another station,” Josh explains. “I spoke to her then about the shearing opportunities on lifestyle blocks, something she agreed was missing skilled workers.
“We were all doing similar roles just separately, and now with a whole team behind us we are a lot more determined to succeed, make a name for ourselves and our company.”
The team were unanimous in their decision that creating the company would be the best way for them all to continue to provide the best services to farmers. Although there was an obvious need in the industry for skilled casual workers, they were still nervous about how the first year would go after creating the company in June 2020.
There really isn’t anything more rewarding than helping other people out. No matter how big or small the job, we find it just as rewarding as the last knowing that we have completed it to a high standard by providing the best people.Top: Lucy Aston fencing. Above: Josh Oden vaccinating calves.
“It would’ve been difficult starting up if we hadn’t been unemployed during lockdown, and the opportunity of the lambing contract at Spring Sheep. Diane and Lucy had already learned the system, completing a couple of lambing seasons before AgriLeaf took over, so we had the experience and then the man-power to tackle the task while learning along the way,” Lachlan says.
The lambing season runs from July – October, and it was allhands-on-deck for the first season as a company.
The season was an enormous success, and they secured the same contract for 2020/2021. Before the season began, they were approached about a lambing contract on another local sheep milking farm, Waikino Station in the Western Bays, where Josh was already farm manager of the dry stock operation. While this meant splitting the team at short notice, AgriLeaf employed more workers to help them over the two units and completed two extremely successful lambing seasons, applying the skills learned from the previous years and training their new employees successfully into the role of lamb rearers.

“While none of us had a background in it, milking sheep are very much at the core of the company and all of our employees now have some experience,” Lucy says.
“While we are definitely not experts, we can apply our dry stock backgrounds and limited dairy background into the role, and it helps that we all thoroughly enjoy the challenge the work provides.”
When they are not feeding lambs, Hannah and Lucy still have AB runs from October – December, while Diane spends her time doing casual shepherding with a team of dogs, fencing and yard work. Josh continues to manage Waikino Station’s dry stock through the company, while Lachlan continues his consultancy with AgFirst year-round, a job he has been doing since AgriLeaf started up.
While everyone agrees the company’s main aim is to provide essential labour, they don’t deny how rewarding the job is for them as well. The diversity and variety of work has allowed them more independence, as well as control over what they do and the high standards they set for all their jobs. As well as excelling in their own abilities, they say working in a team rather than alone has allowed them to expand their own skill sets and those of others. It also
solves the problem of isolation and loneliness farmers face because even when they are working alone, they know they have a team behind them.
“There really isn’t anything more rewarding than helping other people out. No matter how big or small the job, be it shearing ten sheep for a small lifestyle block or drenching and dipping 3000 lambs on a big station; we find every job as rewarding as the last knowing that we have completed it to a high standard by providing the best people for the job.”
Plans for the AgriLeaf team involve encouraging younger people into farming roles. While they are currently only employing staff who already have the required skills for the job, they hope one day they will be able to bring staff on and teach them the skills themselves.
Both Diane and Lucy completed cadetships around Taupo, and Josh completed his training at Smedley Station cadet training programme. All agree this time was an invaluable source of learning for them that is not as readily available to the younger generation anymore.
“It got me into a routine and taught me how hard work helps achieve personal goals. I learned skills that I still use today such as teamwork, communication and working hard until the job is done.” Diane explains.
Lachlan and Diane are working through AgriLeaf with Māori trust farms in the South Waikato, towards a programme that would create a relationship between multiple farms in the area and create a distinctive style of cadet programme.

The programme would allow young people to gain a variety of skills working on multiple farms, and then seek employment on any of the farms once they completed their apprenticeship. The major focus would be on building multiple skills and allowing the younger generation to see what a variety farming can bring to the table.
“We’re not talking about just university students filling their quota on the holidays,” Lachlan says. “Having a degree isn’t everything, if you’re keen to learn and prepared to work hard then that’s just as valuable, and with the correct support and training progression is possible for anyone in this industry.”







Conversations are spinning, online and face-to-face, about the world, our beliefs and at a time of year that can be especially sensitive - especially when there is grief of some sort involved.

While most people have exciting things planned over the festive season there are those who, for whatever reason, are not looking forward to it or perhaps even dread it. There was a time when I just wanted my birthday (which is a week before Christmas and a month to the day before James passed), to disappear. I went from absolutely loving Christmas and New Year to dreading it because suddenly my life changed.
Think about the friend who might potentially be at a crossroad with where to go or what to do this summer. Maybe they have been recently widowed, maybe their relationship has broken up, maybe their children are spending the first new year away from them, maybe they are single and want to be in a relationship, maybe they can’t have children, maybe they have lost a parent… the list could go on.
We can grieve many different things in our lifetime and we can be pretty bloody good at hiding how we truly feel as well, often to our detriment as those around us won’t notice the struggle.
Picture what your life would be like if you were in the shoes of a friend who may be struggling and ask yourself what would you want your friends or family to do for you? It could be that you invite them to spend time with you on your camping holiday or you make the effort to go and spend time with them.
I liked to be kept really ‘active’ during this time of year so ensuring my days off work were full of activities were the best thing for me and my mindset. For example, boating. A favourite pastime of mine - there is nothing like the fresh air rippling through you as you cruise across the lake or up the river, coupled with good food, good chat, swimming and fishing. These days were lifesavers - especially when I didn’t get forgotten about.
I really struggled with this time of year after James died. I had been in our relationship since I was 18 years old and it had never mattered that we didn’t have concrete plans.
Once I was on my own, not only was I grieving and grappling at survival most of the time, I was also left feeling very reliant on friends, hoping they wouldn’t forget about me.
It was particularly hard when people were doing more ‘couple’ type activities that it hit home to me hard, making me
feel more alone than ever. Even if I was invited to do a daytime activity, the empty feeling that rose up inside me once I got home was awful.
We can be quick to judge others, when it comes to their beliefs, behaviours and decisions. I follow a few different grief sites online as it is always good to hear people’s different stories.
People who have lost someone, especially a spouse in this instance, are often judged very quickly by people about moving forward with someone new.
The same person can be told it’s too soon or they should have already moved on or it’s the wrong person or even that they’re disrespecting their late spouse - and the list goes on. These are people whose lives have been thrown into utter turmoil. Destroyed.
So if you know someone grieving in any way shape or form, be kind and judgement-free. They are already battling with so many emotions and simply need support and kindness.
Christmas and New Year, anniversaries,
long weekends, weddings and more are scary times for those missing key people in their life. It exacerbates grief tenfold as it is far more obvious that they are missing and not coming back.

Although you do in fact have a million things to do and are flat out in festive mode, you are bound to have a friend who will really be struggling and the kindest thing people can do is to make some time for them and include them. I will never forget those gestures from people in my life and some of them were so simple.
In a time where people’s opinions seem to be flying left, right and centre, try not to judge and criticise. Instead look at yourself and think about your own goals and maybe making empathy and kindness part of them.
Have a wonderful and happy summer, be grateful for those amazing people in your life and treasure today like it is your last.
We can grieve many different things in our lifetime and we can be pretty bloody good at hiding how we truly feel as well.
Scientists are tracing the flow of hydrogen, oxygen and nitrogen to find out how nutrients flow through water and farms.
By Hardie.Scientists are providing another tool for farmers to trace the sources of nitrogen in their farming systems with the use of natural isotope tracers. Scientists like Dr Troy Baisden have been working on the science of pinpointing periods or locations of excess nitrogen (N). By doing that, farming and catchment groups then know where and how to mitigate nitrate losses.
The tracers work because water and nitrate molecules naturally contain different versions - isotopes - of the elements hydrogen, oxygen and nitrogen. With good instrumentation, these isotopes serve as tracers of water and nitrate, used to observe its progress through a system, or to determine its sources. For farmers, they can be used to find out how nutrients as well as water move through a farm.
Dr Baisden, a professor at Waikato University, and now connecting across Auckland University, Te Pūnaha Matatini, Motu and Land and Water Science, has led teams developing this science for more than a decade. He has been using N isotopes to confirm details such as whether the nitrogen comes from urea or urine, or whether there is another source such as market garden fertilisers or maybe an abandoned septic tank in the catchment. Until now, water testing has shown where high nitrate concentrations exist, but isotope tracers can now reveal why those concentrations are high and where they come from.
Some natural isotope tracers can show whether excess nitrogen levels in a waterway after a high rainfall event comes from runoff capturing urea and urine from the land, or from underground sources. Others identify whether underground water feeding into the waterway has been there for one month or for 20 years. In some catchments, N levels can rise three, four or five times in a storm event, yet he says little has been known about whether the N is from runoff or from underground. Or how water is bypassing soil and running into the stream.

“When and how do we get particular nitrates out of particular catchments? With this we can see where the nitrate excesses are and can look at how we can reduce them by working backwards.”
Research used the natural isotope tracers to work out how they could be used as tools to reduce uncertainties in the sources and magnitude of N losses, to clarify rates of change in N budgets and to identify opportunities to reduce the N excess causing losses to water.
The tracers reveal targets in space and time for potential
Anne
‘When and how do we get particular nitrates out of particular catchments? With this we can see where the nitrate excesses are and can look at how we can reduce them by working backwards.’Streams used for monitoring.
mitigation, specifically N content in clover-ryegrass pastures which seasonally exceed N demand in grazing animals. He says that suggests farmers could use alternate species of feeds to reduce animal urinary N excretion and that would limit soil-derived nitrate (NO3) losses as well as the greenhouse gas emission, nitrous oxide (N20).
Other management decisions could include the timing of fertiliser applications, grazing and cut-and-carry to potentially mitigate excess N and associated N losses.
In Southland, where tile drainage is often used, they found dissolved organic N increased after major rainfalls while nitrates (NO3) remained stable. Dr Baisden says that suggests the ongoing breakdown of soil organic matter releases N, which should be considered in farm and catchment N budgets.

He says much of the work being used in farming and catchments focuses on best practice, such as the Overseer model, but best practice does not always occur and there are sources in catchments that affect N measurements on farms. Models are needed, but he says they need additional tools. Tracers are tools that will be useful in raising issues within catchments by delving into the detail of what is happening and helping people on the ground better observe how the catchment’s plumbing works.
Dr Baisden says most nitrogen sources have unique signatures which identify what it is and what it isn’t, such as urea, urine and fertiliser - that are easy to reduce. Or it may look like soil nitrogen, which indicates that pastures and soils are working well and retaining nitrogen.
Though scientists have been working on isotope tools for the past decade, Dr Baisden says there has been disappointing interest in the work until now. He also says the focus has been mainly on nutrient accounting to support policy without sufficient interest in confirming sources and processes to support farmers and catchment groups to identify and mitigate their nitrogen losses. Now there is growing interest in the research and that is coming from the likes of Landcare Trust and farmers. Landcare’s Nelson-Marlborough regional coordinator, Annette Litherland, became interested in tracking sources of nitrate from work in Golden Bay. Dairy

farmers in the Motupipi catchment are low-intensity dairy farms that have carried out extensive environmental work to improve the river quality, but the nitrate levels remain high in the river. The river is also spring-fed, with water brought from far outside the immediate river edge and she says it is not clear where the nitrate is coming from. Similar cases can be found in springs and aquifers in Tasman.
She says the methods to reduce sediment, phosphate and E.coli are easy to understand as they all involve transport over the ground. But reducing nitrate levels is more difficult. Finding a tool that could identify sources would enable the most appropriate cost-effective mitigation methods to be applied.
Deciding it was time for more discussion on the subject, she organised an online discussion between scientists, industry and farmers from across the country. It was also aimed as an opportunity for farmers to communicate with scientists on the gaps in knowledge around nitrate leaching.
Dr Baisden says the farming industry and wider catchments need the science now to address the issue of nitrate losses, whether that is to improve waterways or to retain nitrogen in soils for farming. He says it is a win-win if farms can retain productive
nitrogen and avoid impacts in water.
The science is still expensive, but he says it has begun to look cost effective compared with the limit-setting costs being imposed on farmers. He thinks there will be more collaboration between farmers and councils to find solutions and he expects that will be driven by farmers and their catchment groups.
Farmers and catchment groups wanting to track nitrate sources using the isotope tracers can work with an isotope scientist to collect samples along with their regular water samples and send them to a laboratory at GNS Science. A catchment coordinator or similar can then work with a scientist to interpret those results so they can be used for practical solutions.
Clover is a many-varied and valuable member of the pasture family. By Karen Trebilcock.
The heat is on throughout the country, ryegrass has headed out and pastures are becoming full of clover.
Some paddocks will even be turning white, red, or yellow with their flowers.
As spring pastures are eaten out, more light gets down to the clovers helping them grow. Plus their optimum growing temperature is about 5C higher than ryegrass which is why it becomes more dominant now and will be stopping your milksolids in the vat from falling.
Just like with ryegrass, there are lots of different varieties to choose from when regrassing or if you’re thinking about oversowing a paddock.
And there is just about a variety for every soil type and climate, so diverse is this little legume.
White clover is the usual choice for New Zealand pasture and is classified by the size of the leaf. Generally, the smaller the leaf size, the more persistent and low-growing the plant will be.


White clovers have stolons on their
Whatever
stems which creep along the ground and each growing point on the stolon can become a new plant.
Large-leafed white clovers, such as Kakariki and Kotuku, grow taller, are more upright, and have thick stolons and robust roots and are higher yielding.
However medium-leaf clovers, such as Huia and Tribute, have more stolon growing points so are more persistent.
Small-leaved clovers, such as wild white clover, are the most persistent of all with lots of stolon growing points but they are so low growing only sheep can usually get a good nibble off them.
Red clovers, which have tap roots instead of stolons, have a red flower instead of a white one and are usually short lived – lasting only two to four years.
Subterranean clover, also known as sub
clovers, are getting their share of the limelight lately for their ability to survive the dry and their early spring growth. They are an annual clover so must be allowed to set seed each year to survive so don’t eat them off at the wrong time.
Lotus major is tolerant of wet and acid soils and shade so expect to see its bright yellow flowers in peat country and on the West Coast. It has underground rhizomes which can store carbohydrates in autumn for overwintering. Lotus corniculatus (birdsfoot trefoil) grows well in low fertility soils in regions with warm, dry summers. And then there are some other varieties that are getting farmers excited.
Persian clover, from the dry areas of Turkey, Iran and Iraq, is self-regenerating and can be grown on its own as a forage crop or used in pasture seed mixes.
clover you choose, you can easily spot the seed in grass mixtures. Clover seed is smooth, small and round.A medium sized leaf white clover.
Crimson clover, known for its colourful tall flower heads, is a fast-growing clover for cooler temperatures.
Whatever clover you choose, you can easily spot the seed in grass mixtures.
Clover seed is smooth, small and round. It’s usually sown at a rate of 3-4kg/ha.
But why should we worry about these little plants, and make sure they’re part of our pasture sward?
Because they are a legume, and legumes (peas, beans and, sorry, gorse) fix nitrogen in the soil from the air which grass doesn’t do.
So, if you are trying to reduce your nitrogen fertiliser usage, then these are the plants you need to think about.
Clover actually struggles in pasture grown with high rates of nitrogen fertiliser.
But it isn’t the clover that does the nitrogen fixing. Legumes have a friendly relationship with a bacteria called rhizobia which hangs out in the nodules of the clover roots. It’s the bacteria in these nodules that take nitrogen from the atmosphere and put it into a form that the legume can use to make protein and grow.
But clover is not great at sharing the nitrogen its buddy rhizobia has grabbed.
The only way grass gets it is when a bit of the clover plant dies and breaks down in the soil and then the nitrogen is released –all part of the nitrogen cycle.


Some overseas websites recommend using herbicides to kill clover plants to speed up this transfer of nitrogen before resowing with more clover seed but maybe letting nature do its thing is a better idea.
And remember, when spraying paddocks for broad weeds, thistles and gorse, clover will take a hammering as well and as some of these sprays stay in the ground, especially in low rainfall areas, which might mean no clover plants for a year or more.
But there is another ingredient in this legume and bacteria nitrogen fixing mix –molybdenum.
Molybdenum is an element (Mo on the Periodic Table you may or may not remember from high school) and a mineral.
The bacteria in the clover roots doesn’t do so well without it, so soils lacking in molybdenum will have lower rates of clover as clover needs its bacteria friend to grow. Luckily molybdenum can easily be added to fertiliser applications but check your soils are low in it first. It doesn’t need to be applied every year and soils high in molybdenum cause all sorts of problems with stock health, especially copper deficiency, so be careful.
Because the bacteria is fixing nitrogen, clovers are high in protein. About a quarter to a third of clover is protein, compared
with grass which is about 10% to 25% depending on the time of year.
So while most pasture only contains at best 30% clover, it’s the clover that is the nutrient powerhouse for your cows.
But just be aware of bloat. Too much clover, just like any good thing, is not good for cows.
As well as protein, clover also contains calcium, chromium, magnesium, niacin, phosphorus, potassium, thiamine, and vitamin C so, for a cow, it’s a bit like popping a multivitamin.
Unfortunately, a few other things like clover for its high nutritional value such as slugs, the clover flea, a few soil-dwelling nematodes and the clover root weevil which was discovered in New Zealand in 1996 and has spread throughout the country probably hitchhiking on bales of hay.
If your clover leaves look like something took a hole punch to them then you have a problem with clover root weevil.
But the great thing about clover is it flowers every year and those flowers turn into seeds and those seeds can stay in the soil for years before they germinate so even if you do nothing, as long as your soil has enough molybdenum, you will always have clover.
And maybe even a few four-leafed ones as well.
By replacing labour and timeconsuming tasks with technology, your herd is closely monitored at all times and you get the most accurate cow data for informed and datadriven decisions.
When pastures are well-managed and your cows are healthy and in-calf on time, you have covered the most important ingredients to reach a 300-day lactation and remain at a calving interval of 365 days. Being a good grass manager is a trade of its own and it’s no less true for being a great dairy herdsman.
What are the cows doing at night and when you are not around them and do they act differently when you are entering the barn or milk them? Watching each individual cow at all times in an unbiased way is simply not possible.
“With cow monitoring technology we are collecting cow behavioural patterns during day and night and translate these into relevant insights related to heat activity, eating, rumination and cow health,” says Sören Bunte, international account manager at Nedap Livestock Management.
Watching cows with the use of technology is not only more accurate, it’s also more time and labour efficient. According to Bunte, there are three important farm tasks in pasture-based systems that are ready for automation: heat detection, health monitoring and drafting. A missed heat directly impacts the calving interval and milk production in the following season and can even have longlasting effects.
Automated heat detection takes the guesswork and errors out and directly improves heat detection rates.
“Our sensor technology (Nedap CowControl) shows a proven >90% accuracy in heat detection and could improve the six-week-in-calf-rate significantly as one of few tools you have with the highest significance. The more cows in-calf early, the fewer cows will be empty at the end of mating. Nedap CowControl also detects non-cycling and irregular cyclers for you, allowing for quick intervention and tens of dollars per cow saved,” Bunte says.
High milk yield can only be achieved with healthy cows. To prevent a high veterinary bill or a lost cow, you need to be able to quickly intervene when there is a potential health issue. Behavioural observations of the cows are important in detecting illness or injury. But it is difficult to actually see a sudden drop in feeding and rumination time with the human eye that could be linked to a potential health issue. A cow is trained to act as a tough cookie and hide when they are not feeling well. Nedap CowControl turns behavioural information into relevant health alerts, to-do lists and reports so the farmer can proactively manage the health of each cow and the entire herd.
“Our sensors collect cow data 24/7 and 365 days per year and notify on possible health issues. This results in the early detection of mastitis (up to two days before clinical signs are shown), digestive disorders and other important health issues. These insights can also help veterinarians to make decisions based on the cow’s behaviour of the last 24 hours,” Bunte says. A healthy cow is not only free from disease but is also fit and robust, reflected in the body condition score (BCS).
“A drop in milk production can be hard to regain. A cow has to work hard to eat as much as possible in a day. Our health monitoring tool calculates the feeding and rumination times for you to ensure you the cows have enough to eat year-round,” Bunte explains.

Seamlessly integrating Nedap CowControl with drafting gates makes it possible to automatically separate cows needing to be inseminated or treated according to heat and health alerts, without having to touch them. With increasing herd sizes and reduced labour force, replacing visual heat detection and tail painting is often the first reason for farmers to invest in cow monitoring technology and the numbers tell the tale.
The first step in automating labour intensive tasks often lies in starting with a
solid and accurate heat detection system. But the demands of today require that technology is not a stand alone heat detection system, but also picks out the sick cows at an early stage. Pasture-based dairies therefore profit from an all-in-one dairy herd monitoring and management system. Bunte addresses: “Complete cow monitoring adds value to every stage of the production cycle and gives you an extra pair of eyes during the fresh cow period, the breeding period, the pregnant (mid- to late lactation) and close up period. When there are less health issues and you can successfully inseminate all cows in your preferred time window, you have more time for other management tasks and proper planning for calving, mating, cow replacement or negotiating ever important contracts. It also creates more peace of mind year-round and time for a welldeserved break after the peak season.”
For dairy farmers it’s an everyday occurance to juggle all dairy farm activities at once and there aren’t simply enough hours in a day to watch each cow manually. But they can’t afford to miss a heat or important health issue. This challenge is only getting bigger when dairies increase in size and external labour is hard to find or halted due to the Covid-19 restrictions. It’s therefore time to start automating. More pasturebased dairies are therefore turning to the benefits of using cow monitoring systems to automate labour intensive tasks and get accurate data and actionable insights regarding heat, eating and health. Cows talk to us via different ways. Technology is here to listen with us.
More? visit www.nedap-livestockmanagement.com/ dairy-farming/solutions/nedap-cowcontrol
Lincoln University researchers have received United States Food and Drug Administration approval for in-human clinical trials of their gene therapy for the treatment of CLN5 Batten disease, a fatal neurodegenerative disease affecting children.
The CLN5 form of Batten disease appears early in a child’s life and causes brain degeneration manifesting in devastating symptoms including vision loss, seizures, dementia, abnormal movements and inability to communicate. Sufferers typically die in their teens.
Until now there has been no cure and no hope of treatment, but the Lincolndeveloped gene therapy is a potentially transformative treatment for the CLN5
patient community. Over the past decade, Professor David Palmer and Doctors Nadia Mitchell and Samantha Murray have been developing their gene therapy in sheep with a naturally-occurring form of the disease.
“The brains of sheep with Batten disease shrink, as do the brains of humans with the condition,” Dr Mitchell says, .
“When we have replaced the missing gene in affected sheep before they display symptoms, in most cases the disease has been prevented. When we replace the gene after the sheep begin to display symptoms, the therapy has slowed the progress of the disease.”
Sponsored by Neurogene Inc (USA), a company founded to bring life-changing
Northland beef farmer Mack Lynn has won the MaxCare feeder competition just in time for Christmas.

Mack Lynn and his fiancé Mathilde Schwarz of Lynn Brothers Farm, Haruru, Bay of Islands, are the winners of the McKee 60 Teat Gravity Calf Feeder, valued at $7795. Lynn Brothers specialise in rearing a mixed variety of calves which are on-sold to other farmers or finished on the property. They have recently made a significant investment into expanding their rearing sheds and increased the number of calves reared.
“It was perfect timing as we were looking at purchasing a new feeder,” Mack says.
“When we started using MaxCare, we were very impressed by the mixability and consistency of the product, which positively contributes to the rearing of our calves.”
Celebrating their third anniversary in the New Zealand market, MaxCare in conjunction with PGG Wrightson ran an in-store competition through the 91 PGG Wrightson stores across both North and South Island, with more than 747 farmers entering.
MaxCare specialise in infant animal nutrition. The MaxCare range of milk replacers has been specifically formulated using high quality ingredients to ensure optimum health and nutrition in infant animals. MaxCare products are available in Australia and New Zealand.
genetic medicines to patients and families affected by rare neurological diseases, the Lincoln team have received US FDA approval for their Investigational New Drug Application, clearing the way for the first in-human clinical trials of their CLN5 gene therapy. The first clinical trial is expected to initiate at the University of Rochester (New York) in the first half of 2022.
“The FDA approval is life-changing news, not just for our research team, and for the university, but especially for thousands of Batten disease patients globally, “ Dr Mitchell says.
More? Visit research.lincoln.nz for more information on the world-leading research being undertaken at Lincoln University.
As NZ Dairy Exporter counts down to its centenary in 2025, we look back at the issues of earlier decades. 50 Years Ago – January 1972.

A chart to provide a visual reminder on the milking shed wall can be a useful aid when noting and recording mating success in the herd, says Dairy Board consulting officer, Mr Fred Barnes.
Various systems can be used including cow numbers listed in columns and these are crossed out as cows are served. On return services, three different coloured maker pencils can be used when striking out. This will show short, normal or long intervals.
Working the Laurentic on December 22 and 23, Whangarei waterside workers loaded 2786 tons of butter for the United Kingdom market.
On the Wednesday the watersiders loaded 1315 tons of butter and this, according to Dairy Board records, came within 137 tons of the record tonnage of butter loaded into one ship in one day in New Zealand. That record, established in October, 1969, was also set by Whangarei watersiders.
The Dairy Board Chairman, Mr F. L. Onion, CMG, sent telegrams to the union and to the staff of the Auckland Farmers’ Freezing Co.’s Whangarei cool store congratulating them on their performance.
As the result of the dairy industry’s priority programme of product development, the Dairy Board expects to export at least a dozen new classes of dairy products this
season. In a statement announcing this, Dairy Board Chairman, Mr F. L. Onion, CMG, said that most of these had been under development for some years and that many other new products were in the course of development.
“While the future of each of these products cannot be foreseen, it will be surprising if some of them do not become substantial income earners for New Zealand,” said Mr Onion.
“Today our dairy companies are producing 40 basic products from milk, including butter of various types, milkfat and ghee, several variations of cheese, natural and processed, milkpowders containing different proportions of milkfat and non-fat solids and infant milk foods.
“Among the new products are Gouda and Cheshire cheese, flake skimmilk cheese, new types of ghee, instant wholemilk powder, new types of baby foods, therapeutic foods based on casein, and soluble whey protein.”
A plan for progeny testing Polled Hereford bulls for AB has been approved in principle by the Herd Improvement Council. The council decided to buy up to 30 bulls each year for this purpose from a “wide variety” of herds.
The Assistant Director of the Dairy Board’s Farm Production Division, Mr H. J. Clifford, said the scheme could be expected to result in the bulls finally kept for use after the progeny test, leaving progeny that were 30lb a head higher liveweight at 20 months than progeny of
the average bull of the group. Based on 40,000 animals at $3.75 extra a head, this would put an additional $150,000 into farmers’ pockets each year.
The use of Polled Hereford semen fluctuated from about 1.5 per cent to 2.5 per cent of total inseminations from 1959 to 1968. In 1969 it was up to 4.2 per cent and by 1970, when there were 60,350 inseminations with Polled Hereford semen it was 5.5 per cent.
The change to metrication in herd testing will take place at the start of the 1973-74 season provided that dairy companies are paying to suppliers on the metric system at that time. This has been decided by the Herd Improvement Council.
The council has also granted permission for associations to use the Milko-tester for fat testing immediately provided they collaborate with the Dairy Division of the Department of Agriculture in installing and operating the equipment.
The council has also approved Farm-acy ear tags as an alternative to ear tattooing for official identification of cows.
• Thanks to the Hocken Library, Dunedin.
There’s no point hanging on to girls who are not going to pull their weight in the herd. LIC milk tests can swiftly sort out your top milkers from your lawnmowers, giving you the information you need to make management decisions. But when getting a combination of milk tests done, you can access much more.
Like uncovering some of those unwanted issues like Johne’s disease, identifying which animals may carry the valuable A2/A2 gene or double checking pregnancy status. Plus a milk test is non-invasive, reduces stress and helps you build a more profitable herd, year on year.
Drop a call to your local LIC Agri Manager to book your combination of milk tests.

There's always room for improvement
A milk test can tell you more than herd health.